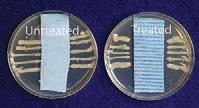

Crothall Laundry Services breaks ground in
Calif.
WAYNE, Pa. — Crothall Laundry Services has started construction on a new, stateof-the-art, 60,150-square-foot laundry facility in Manteca, Calif.
Encompassing more than five acres, the new facility is projected to open in summer 2014 and will offer centralized healthcare laundry services to both Northern and Central California.
Located within the CenterPoint Intermodal Center (CIC) in Manteca, the plant will be near several key transportation hubs. The building will be LEEDcertified, and have the capacity to process more than 55 million pounds of linen annually, Crothall says.
“Crothall chose to locate within CIC-Manteca due to flexibility in the design and construction of our build-tosuit laundry facility. However, we are excited for several reasons about this new location,” says Crothall President Steve Carpenter.
The facility will be the second ground-up, hightech, state-of-the-art laundry built by Crothall. Its last project, also engineered by Ian Bigelow, was an 82,950-square-foot plant in Oak Creek, Wis.
“We are excited about being able to provide healthcare customers in the Northern and Central areas of California with laundry and linen service that is flexible, green and has state-of-the-art efficiencies, lowering costs for healthcare providers,” says Brian Dunn, national director of sales. ALN
Alliance Laundry moves forward with $46 million expansion
RIPON, Wis. — Alliance
Laundry Systems is moving forward with a $46 million expansion project, less than two months after completing a production capacity increase, the company reports.

The largest expansion in the company’s history, the project plans call for adding 106,000 square feet of space for manufacturing and assembly, says Alliance.
The company anticipates breaking ground for the expansion in February, and expects the added production capacity to be online in the second half of 2015.
Currently, its corporate campus in Ripon occupies five buildings on more than 58 acres, including two manufacturing plants, an engineering center and test lab, and distribution facilities, for a total of more than 1 million square feet.
Alliance plans to immediately hire an additional 150 manufactur-

ing and office staff to support the added capacity, the company says, while the majority of production employees will be hired in 2015.
The project received final internal approval after Alliance had secured agreements with its union, the United Steelworkers Local 1327, the City of Ripon and Fond du Lac County.
“Alliance makes the most reliable and durable laundry equipment available, and demand for our products keeps growing, both in the United States and overseas,” says Mike Schoeb, Alliance Laundry president and CEO.
“Our core philosophy is to delight our customers with each and every interaction, provide the best products in the industry and excel in our service levels. The dedication of our people is what puts
“A designer knows he has achieved perfection not when there is nothing left to add, but when there is nothing left to take away.”
— Antoine de Saint Exupéry
“The world always seems brighter when you’ve just made something that wasn’t there before.”
— Neil Gaiman
“Design is the conscious effort to impose a meaningful order.”
— Victor Papanek
Anumber of laundry projects are completed around the country each year, resulting in brand-new or retrofitted plants primed and ready to convert soiled goods to clean textiles for the benefit of end-users and customers.
But before a plant goes online, there can be months, even years, of project preparation. As a way to celebrate all the hard work that goes into designing, building and equipping a modern laundry plant, American Laundry News created this Designing Success feature to spotlight portraits of memorable plant installations.
And so institutional/OPL, commercial and industrial laundry equipment manufacturers, as well as firms that offer design-build, engineering and mechanical contracting services, were invited to tout their latest and greatest projects of the past two years.
Take a look at their tales, starting on page 12...
Coaching staff to save money, protect resources
BY CARLO CALMA, EDITORIAL ASSISTANT
PHOENIX — All good sports teams rely heavily on the plays that their coach designs to not only win a game, but to have an overall successful season.
The Association for Linen Management (ALM) recently hosted a webinar, Coaching Staff to Save Money and Protect Resources, to apply the same principle to laundry standards, and to detail what calls a laundry manager can make to provide staff a winning production strategy.
Bob Corfield, president of Laundry Design Group, was the presenter. “Workplace coaching is


the process of equipping people with tools and knowledge to fully develop themselves [and] to affect their commitment to themselves, and [the] company,” he says.
Develop Coaching Skills
Before diving into the coaching process, Corfield advises managers to self-assess their skills and “core competencies” in leading a group, adding that coaching is different than managing.
“Coaching is a buy-in concept,” he says. “It’s … about identifying the team and/or the individuals that are around you [to] try to bring their skill level, as well as other capabilities, into the optimal position of being able to achieve
your outcome.”
He adds that coaching is a learning process for many. “It’s not something that is intuitive to most people, it is not something that is easily learned,” says Corfield.
“In some cases, you need to be trained and … then understand what your capabilities are going forward, looking at your coaching competency through feedback and ongoing coaching.”
Create a Game Plan
The first step to successful coaching, according to Corfield, is having a game plan that has a clear view of the end goal. “Using a sports analogy, you have to communicate to the ownership what
your goals are and have to communicate to the people around you … so [you are] able to meet that goal,” he says.
One aspect Corfield advises coaches and managers to be aware of in the game-planning process is the importance of being flexible.
“No program, regardless of how well [you] designed it, is actually going to meet your overall goals without having a full understanding that you may have to … adapt to limitations within the context of a plan,” he says. “As much as a plan is a plan, it may not necessarily be the hard, fast and only rule to be able to get to that goal.”
Panel of Experts
What records should you keep to ensure you’re being productive?
Laundry Layout
Many variables, conditions affect how to approach an OPL design.



DECEMBER 2013
Late News
Newspaper of Record for Laundry & Linen Management www.americanlaundrynews.com Volume 39, Number 12
The
INSIDE [6] [10]
[16]
See ALLIANCE on Page 2
See COACHING on Page 11
Survey: Loss of customers greatest fear for managers

CHICAGO — Laundry managers weighed in on “spooky” management scenarios in November’s American Laundry News Your Views survey, with the majority (32.9%) saying they are most frightened by the prospect of their biggest customer deciding to go with another textile care provider.
Others were more frightened by “[their] laundry’s electricity [going] out for a long period of time” (26.3%); “a key piece of processing equipment is not operational” (14.5%); or “OSHA [calling] after receiving an anonymous complaint” (13.2%).
Equal shares of 6.6% say their supervisor directing them to cut next year’s budget by 10%, or “other” types of scenarios, such as a fire occurring at their facility, are the most frightening.
Some managers have already faced these scenarios at their laundry.
“[A] hurricane took out electricity for 72 hours and blocked roads with trees,” one says.
“[We lost] a customer to another company that does not do as good a job as us, and costs more, due to the ignorance of the customer’s knowledge,” says another.
A third manager says, “We had someone fake an injury and try to sue for worker’s [compensation].”
The majority of laundry managers say the recent government shutdown “wasn’t scary at all” (59.2%), while roughly 30% did admit to feeling a “bit anxious” about it. Small shares were “pretty frightened by the end” (7.9%), while some were even “scared out of [their] wits the whole time” (2.6%).

While many managers say they were not directly affected by the shutdown, some were.
“We had government accounts that were closed [that] we could not service and … charge for, so we had a loss of revenue,” says one respondent.
“We have government contracts and it slowed the checks up, but we managed,” says another.
Overall, the laundry managers polled were displeased by how the shutdown was handled.
“In my opinion, Congress caved [and] gave up their bargaining chips,” says one respondent. “They should have stood their ground.”
“[The shutdown] never should have happened,” says another. “If a business was run the way the government is being run, the business would never make it. They need to get a clue and start actually thinking about the good of the country and all of the people in it.”
While the Your Views survey presents a snapshot of readers’ viewpoints at a particular moment, it should not be considered scientific.
Subscribers to American Laundry News e-mails are invited to take the industry survey anonymously online each month. All managers and administrators of institutional/OPL, cooperative, commercial and industrial laundries are encouraged to participate.
Publisher
Charles Thompson
Phone: 312-361-1680
E-Mail: cthompson@ americantrademagazines.com


Editorial Director
Bruce Beggs
Phone: 312-361-1683
E-Mail: bbeggs@ americantrademagazines.com
Digital Media Director
Nathan Frerichs
Phone: 312-361-1681
E-Mail: nfrerichs@ americantrademagazines.com
Production Manager Roger Napiwocki
Contributing Editor Jean Teller
Editorial Assistant Carlo Calma
Advertising Sales
National Sales Director

Donald Feinstein
Phone: 312-361-1682
E-Mail: dfeinstein@ americantrademagazines.com
Office Information
Main Phone: 312-361-1700 Fax: 312-361-1685
Subscriptions
630-739-0900 x100 www.americanlaundrynews.com
American Laundry News (ISSN 1091-9201) is published monthly. Subscription prices, payment in advance: U.S. & possessions, 1 year $39.00; 2 years $73.00. Foreign, 1 year $89.00; 2 years $166.00. Single copies: U.S. & possessions $7.00; Foreign $14.00. Published by American Trade Magazines LLC, 566 West Lake Street, Suite 420, Chicago, IL 60661. Periodicals postage paid at Chicago, IL, and at additional mailing offices.
this philosophy into action.”
“Our continued strong partnership with the City of Ripon, Fond du Lac County and our union allows projects such as this to move forward quickly,” adds Schoeb.
Local officials, including Fond du Lac County Executive Allen Buechel, county Economic Development Corp. President Steve Jenkins, City of Ripon Mayor Gary Will and city Administrator Lori Rich, worked closely with Alliance to move the expansion forward, says Schoeb.
“Alliance Laundry’s expansion is great news for Fond du Lac County and its residents, and we’re proud to be a partner in making it
possible,” says Buechel.
Jenkins says the project will have a positive ripple effect in the county, including the creation of 71 new jobs in addition to the 150 being added at the plant.
Rich praises Alliance for continuing to build on its success.
Will agrees, saying, “Alliance Laundry offers our community an unparalleled opportunity for job growth, and by providing financial assistance to a local business, we will help ensure that Alliance Laundry continues to expand its business right here in the city.”
Alliance Laundry Systems designs, manufactures and markets commercial laundry equipment used in on-premises laundries, multi-housing laundries and Laundromats under the Speed Queen, UniMac, Huebsch, IPSO and Cissell brands. ALN
POSTMASTER, Send changes of address and form 3579 to American Laundry News, Subscription Dept., 440 Quadrangle Drive, Suite E, Bolingbrook, IL 60440. Volume 39, number 12. Editorial, executive and advertising offices are at 566 West Lake Street, Suite 420, Chicago, IL 60661. Charles Thompson, President and Publisher. American Laundry News is distributed selectively to qualified laundry and linen management and distributors in the United States. No material appearing in American Laundry News may be reprinted without written permission. The publisher reserves the right to reject any advertising for any reason.
© Copyright AMERICAN TRADE MAGAZINES LLC, 2013. Printed in U.S.A. Association
MEMBERSHIPS
2 DECEMBER 2013 | AMERICAN LAUNDRY NEWS www.AmericanLaundryNews.com
for Linen Management
ALN INSIDE: December 2013 • Vol. 39 | No. 12 [4] Columnist at Large: Soiled-Linen Collection There are several factors to consider when determining what soiled-linen collection system is best for a facility [6] Panel of Experts: Proper Recordkeeping To ensure your laundry is achieving top production, these are the records you should be keeping, experts advise [10] OPL 101: Designing On-Premises Laundry Creating a laundry with optimal workflow boosts employee efficiency while cutting expenses [12] Designing Success Companies share their portraits of memorable laundry plant installations from the last two years [16] Product Showcase: Detergents, Chemicals & Injection Systems [18] Trade Ticker [19] Career Track
Alliance Continued from Page 1
Gurtler has the solution.
Everyone in the Healthcare Laundry field has experienced the skin sanitizer stain that won’t go away. Now you can prevent those stains in one washing cycle with the new patent pending Magi-ClensTM chemical laundry product from Gurtler Industries. Plus you can eliminate the costly changes you made to avoid the dreaded permanent stains from Hibiclens® or similar Chlorhexidene Gluconate (CHG) products that your healthcare partners use.
And you will be able to address those infection control issues you have faced. We specialize in laundry chemical product technology...it’s our main focus. That’s why we have developed some of the most advanced and trusted laundry chemical products in use today. New Magi-Clens is only available from Gurtler Industries.



Contact your local Gurtler sales consultant today for a free magical demonstration!




Magi-Clens™...eliminates skin sanitizer stains like magic!


Gurtler...The Laundry Chemical Experts, Family Owned & Customer Driven! The
Call Gurtler today! 1.800.638.7300 or visit our website at www.gurtler.com Come see for yourself. Stop by booth #2210 ©2013, Gurtler Industries, Inc.
Pink Monster
Hibiclens is a registered trademark of Mölnlycke Healthcare US, LLC and is not affiliated with Gurtler Industries, Inc.
Ticking off the days til...
s we tick off the days on the calendar during this final month of 2013, it presents us an excellent opportunity to look back over the year and see how far we’ve come.
Recognizing the efforts that go into developing a laundry project from start to finish, we’ve created a special feature this month called Designing Success. Our intent was to offer manufacturers and designers the chance to “paint” portraits of their memorable plant installations from the past two years.
Ranging from a small onpremise laundry serving an outpatient healthcare facility in
From The Director’s Chair BRUCE BEggS
Pennsylvania, to a prison laundry facility in the Hawaiian Islands, to a mammoth healthcare cooperative plant in Canada, our package
has a little bit of everything. I was intrigued by Kannegiesser’s tale of having to fast-track a replacement for a tunnel washer destroyed in a traffic accident while en route to a plant-in-progress.
Elsewhere in this year-ender, we’ve got stories covering topics like recordkeeping and benchmarking, plant design, and coaching up your staff.
Here at American Laundry News, 2013 presented us with an opportunity to reach you in even more ways. What? I’m afraid I can’t say more just now. You’ll have to wait til next month (year) to tear the paper off that gift! ALN
AmeriPride pilots alternative fuel program in several markets
MINNEAPOLIS — AmeriPride Services, which supplies linen and uniform rental services, has launched a pilot program that will test three new types of alternative fuel vehicles in an effort to positively impact the environment and assess the impact on the company’s overall operations.
Compressed natural gas (CNG), propane and plug-in electric vehicles are to be tested this fall and throughout the upcoming year.
“We have one of the largest fleets in the industry, so we have the capacity to put some resources towards reducing emissions while exploring the impact on fuel costs,” says Andrew Steiner, vice president of marketing and customer operations. “We feel it’s our responsibility to consider and pilot programs utilizing alternative fuel options and support the advancement of these new technologies.”
Compressed natural gas is a cleaner-burning fuel that is pro-
duced almost completely in the U.S., the company says. It produces less carbon emissions and lowers exposure to fuel price rate increases.
Five CNG trucks were deployed in Omaha, Neb., in August and five more in Oklahoma City in October. In Omaha, the Metropolitan Utilities District (MUD) is providing substantial discounts on fuel and has provided grant money to help offset the incremental ‘upfit’ costs, AmeriPride.
AmeriPride is also testing five propane trucks in Topeka, Kan. The propane vehicles are expected to have less price volatility and lower vehicle costs than diesel. In addition, preliminary estimates would project a reduction of 17% in greenhouse gas emissions.
Next year, electric trucks will be deployed in Los Angeles and Fresno, Calif. They are expected to have lower maintenance costs and zero gas emissions. In addition,
AmeriPride is eligible for state and federal government financial incentives for the incremental upfront costs of the vehicles.
“This alternative fuel program is a part of a larger company initiative to reduce energy consumption and our carbon footprint,” Steiner says. “We’ve already replaced many of our cargo vans with fuel-efficient sedans and rerouted a majority of our service routes to reduce mileage. We’ve also incorporated better controls to reduce idling and speeding and implemented better training and communication with our drivers to increase awareness and promote behavioral change.”
AmeriPride also is rolling out double-decker semi-truck trailers that have twice as much cargo capacity and will greatly reduce fuel and emissions. The trucks have been deployed in Springfield, Mo., and will also be deployed in Syracuse, N.Y., and Memphis, Tenn., the company says. ALN
AT LARGE Eric L. Frederick, RLLD
Which soiledlinen collection method is best?

Laundry managers often are used as a resource when it comes to various linen handling issues within a facility. I was recently asked to discuss, with a director of nursing, the pros and cons of placing a soiled-linen hamper in every patient room.
My initial statement was that I would not recommend it. I quickly searched the Internet and was disappointed with the lack of material available on the subject. There are a number of factors that must be considered when determining what soiled-linen collection system is best for a particular facility.
Space was a major consideration in my discussions with this facility. The facility had been cited on many occasions for having items in the hallways. It was considering placing computer terminals in every room to eliminate the computers on carts that are used in many hospitals, and often clutter the hallways. Having linen hampers staged in the hallway was not considered a viable option.
Soiled-linen hampers could only be used in a utility room that was often many steps away from a patient room. Space was available in the majority of patient rooms to accommodate a hamper stand. I have been in other facilities where linen hampers are strategically placed in the hallways so that one hamper can handle three to six rooms. What works for one facility might not work well for another one.
PRoPERLY hANDLINg SoILED LINEN WhILE StILL DELIvERINg hIgh-qUALItY
•
•
PAtIENt CARE CAN BE A ChALLENgE.
Infection control was another major issue. The need to be able to properly handle soiled linen from an infection control standpoint while still delivering high-quality patient care can be a challenge. The real obstacle is how best to handle the linen while dealing with a patient in the bed. The need to make sure the linen is changed and the patient is protected during the process often caused nurses to place soiled linen on the floor or in a chair until the care was completed. The placement of soiled linen in a chair or on the floor violated the facility’s established infection-control procedures.
The ideal soiled-linen hamper stand for this facility was one with a foot-pedal-operated lid, so that once the soiled linen was picked up and held away from the nurse’s body, it easily could be placed into the hamper. The ability to open and close the lid in a handsfree manner allows for the proper handling of soiled linen.
What is the potential impact of placing a hamper stand in each patient room on the circulating linen system? Obviously, the hospital will need to greatly increase the number of hamper stands in the facility. It also will require a change in how soiled linen is collected. Who will be responsible for going into each patient room and changing out the soiled-linen bag? How frequently will the bag be changed? There is a strong likelihood that the facility will end up using more hamper bags than before, because bags will be changed on a preset schedule instead of when they are full.
The facility will need to increase its circulating linen inventory, because the soiled linen will not be collected as quickly as before. The use of a soiled-linen hamper stand in each room has added another storage location to the circulating linen system.
As I worked with the various impacts of making the change, I came to realize that my goal was to make sure that the facility had considered all the possible factors linked to the possible change. I simply wanted the director of nursing to make the best decision possible based on all the key factors for her facility.
Eric Frederick is director of laundry services for Carilion Laundry Service, Roanoke, Va., and a past president and manager of the year of the Association for Linen Management. You can reach him by e-mail at efrederick@carilion.com.


4 DECEMBER 2013 | AMERICAN LAUNDRY NEWS www.AmericanLaundryNews.com Top Stories Appearing on AmericanLaundryNews.com for the 30 Days Ending November 15 (WE) = Web exclusive news • Goodwill Plans to Process 40 Million Pounds Yearly... • Crown Uniform & Linen Service Breaks Ground for New Facility • Galls Acquires Roy Tailors Uniform Co. • TRSA Honors Senior, Carter with Lifetime Achievement Awards
Standard Textile’s Rau Retires, Lee Named Successor Columnists/Features • Vinoy Renaissance Relies on OPL for Good Night’s Sleep • Keeping Up with Today’s Trendy Textiles
OPL 101: Protecting a Hotel’s Luxury-Linen Investment
Saving Money Through Water Evaporation Credits
Celebrate Your Successes as Often as You Can our sister websites From AmericanDrycleaner.com: • Pollution Liability Coverage Protects Against Contamination...
Convenience Converts Customers From AmericanCoinOp.com:
•
•
•
•
•
Brain Wash Café and Laundromat Serves Up...
NC Laundromat Brightens Store Through LED Retrofit
A
COLUMNIST
ALN



PAnEL of ExPERts
What records should we keep, and why?
With a Five Diamond property, such as the one where I work, the most important measurements are those related to quality, particularly the number of rejected and discarded pieces. This information is useful in determining effectiveness of both the laundering processes and the wash chemicals.
can’t manage what you don’t measure.” No matter who said it first, this is a truism for any enterprise, including commercial, institutional and industrial laundries.
When you visit your doctor, whatever the reason, he or she will always start by taking your vital signs.
what gets measured is what gets done.” That frequently used quote, attributed to management guru Peter Drucker, is the mantra when discussing performance management. At Franklin W. Olin College of Engineering, the catchphrase is “what gets measured is what gets improved.”
The fact of the matter is, however, that what gets measured doesn’t always get done; what gets measured only sometimes get improved. What does get done and what does get improved are those areas that get measured, analyzed and acted upon.
Most laundries today have solid tracking systems in place to monitor and record production, chemical usage, rewash, etc. The differences between those laundries that run well and those that do not are the processes in place to interpret the data and, most importantly, the mindset to take the appropriate action to improve efficiencies.
At the hotel laundry, soil sorted and loads washed are tracked by the pound. Loads dried are tracked in the same manner. All finished goods are tracked by the piece. All areas are tracked hourly. These numbers are used to measure both the efficiencies of the operators and the equipment. The numbers are posted for all operators to see, along with the appropriate target (standard).
Employees typically want to know where they stand relative to expectations, and each other. Since the employees have access to the same real-time information as I do, these postings serve as an excellent motivational tool.

In conjunction with daily production statistics, the number of occupied rooms and dining outlet covers also are tracked daily. This establishes both piecesper-occupied-room and piecesper-cover ratios that facilitate proper scheduling and budgeting of labor.
Tracking discarded linen, as an adjunct to monthly inventories, also allows for a more accurate linen replacement program.
I have always found pieces produced to be a better indicator of performance than pounds produced. My philosophy has been “measure by pounds, manage by pieces.” Consequently, the focus is more on pieces per operator hour than the traditional pounds per operator hour.
Chemical inventories are conducted weekly. This data is used to calculate both the cost per hundredweight, to measure costeffectiveness, as well as establishing daily chemical usage, which facilitates “just in time” ordering, significantly reducing chemical storage space.
The hotel laundry also operates a full-service drycleaningand guest laundry facility. The number of pieces washed, dry cleaned and pressed are tracked daily. Some of the records that must be maintained are weekly leak inspections, weekly maintenance checklists, weekly emergency preparedness checklists, perchloroethylene usage and hazardous-waste management logs.
One “out of the ordinary” measurement that I conduct is extrapolating clean weight production from pieces produced. In this way, I can determine highly accurate soil factors and reject percentages, as well as verify the accuracy of the production records.
For laundry professionals, taking the vital signs of your business on a regular basis will yield the same benefits as a visit to your doctor, allowing you to see trends, identify potential problems and implement solutions, hopefully before they begin to negatively affect your bottom line.
While I am certain that every business tracks sales, revenue, profit and other financial measures on a regular basis, too often these are lagging indicators of an enterprise’s overall health. Tracking key productivity and performance metrics of your plant often will provide the leading indicators that you need to ensure profitability.
Labor is usually one of the largest recurring expenses (if not the largest recurring expense) for commercial and industrial laundries, and is therefore one of the most critical measures to track on a regular basis.
In our industry, the metric we use to measure labor utilization and to benchmark against past performance is pounds per operator hour (PPOH). By adding up the total number of direct labor hours used in production, and dividing by the number of pounds produced, a good laundry manager can begin to understand the health of his/her plant.
Make certain that indirect labor (management, sales, administration, logistics, etc.) is not included, so that you can get a true measure of the productivity of those who actually pull work through your plant.
Hiring a consultant to perform time and motion studies will result in the development of accurate production standards that are specific to your facility. Once standards have been determined, implement a system for tracking employee productivity and enter the data into a production report each day, so that you may compare expectations to achievements.
Supervisors should praise (publicly) those who meet or exceed expectations and counsel (in private) those who fall below expected productivity. The results also should be posted on a daily and weekly summary to provide additional peer pressure to help drive performance in the positive direction.

Tracking overall and individual productivity is important, but too often managers neglect to discount what appears to be poor performance when maintenance and downtime are really to blame.
As a result, you should track downtime on your equipment any time a piece of machinery is out of commission for five minutes or more. In this way, not only can you gauge the effectiveness of your engineering and maintenance teams, you also can ensure that line employees aren’t penalized for events outside their control.
In addition to labor, utilities are also counted among some of the largest expenses that laundries incur on a regular basis. Tracking your utility usage (gallons of water per pound, kWh of electricity per pound, and Btu of gas per pound) provides similar vital signs to indicate potential issues of concern.
customers pay you to wash their items and return them to their businesses clean, sorted and properly finished, but they do not pay you for rewash. Every time you have to put items back through your plant, you are wasting time, labor, chemistry and utilities. When your rewash percentage goes up, it’s time to look at many factors, including wash formulas, water softener operation or problems with finishing.
Finally, it is tempting to try to compare your plant’s vital signs to those of your peers and colleagues. Bear in mind, however, that vital signs vary based on factors such as product mix, equipment vintage, levels of automation and quality of maintenance.
A good manager will keep regular track of all stated metrics on a regular basis, charting them, sharing them with the entire team, and constantly striving to learn from what they indicate, thereby improving the operation as a result. In order to more efficiently manage, you must measure as many aspects of your operation as possible. By monitoring these metrics, you will start to see trends that lead to cures for what may be ailing your operation.
An old management adage (often misattributed to W. Edwards Deming) states: “You

Measuring and tracking PPOH is a great macro tool for determining whether or not your plant is operating at the most efficient levels, but the only way to know whether or not each of your departments, and each department’s employees, are working at peak efficiency is to implement engineered production standards for each job and product category in the production area.
Assign someone responsible to start taking gas-, electric- and water-meter readings at the exact same time every day your plant is operating. Subtract yesterday’s readings from those you take down today to obtain your usage for the past 24 hours, and divide those amounts by the poundage produced during that same time period. Then track these numbers on a spreadsheet (and resulting bar graphs) just as you do your PPOH.
Another significant vital sign that every manager should track is rewash as a percentage of overall poundage produced. Your

Every manager should remain abreast of vital information as to the efficiency of his/her operation. Not only is employee production (how well an employee meets the standards set) important, but a wide variety of data is needed to measure and therefore promote optimal performance.
Information regarding inventory costs/control (including supplies, linen, chemicals, etc.), utility costs/savings opportunities, equipment operating efficiencies/ asset utilization, pounds per operator hour, plant layout/workflow, route efficiencies, maintenance
6 DECEMBER 2013 | AMERiCAn LAunDRy nEws www.AmericanLaundryNews.com
“To ensure that the laundry I manage is achieving top production on an ongoing basis, what records should I be keeping and why? Do you track anything that might be considered out of the ordinary?”
Healthcare Laundry
Judy Murphy, RN, BSN, CLLM, RLLD
North Mississippi Medical Center (NMMC) Tupelo, Miss.
Hotel/Motel/ Resort Laundry
See EXPERTS on Page 8
Charles Loelius The Pierre New York New York, N.Y.
Consulting services
David Bernstein Turn-Key Industrial Engineering Services Charlottesville, Va.
®





HOSPITALITY SOLUTIONS









aDi-american Dawn manufactures, imports, and distributes textiles for hospitality, food and beverage, healthcare, industrial, microfiber, home fashion and salon markets worldwide. aDi offers textile collections in bath, pool, kitchen towels, bed linens, robes and table linens; as well as top of the bed accessories from duvet covers, bed scarves, matelasses and decorative pillows.

Villa Di Borghese™ hospitality products are fashioned from the finest materials; meticulously designed to capture an exquisite sense of Italian beauty, fashion and style.

10 Distribution centers across north america hospitality@americandawn.com 800 821 2221 americandawn.com
collection
The gold standard in textiles; including towels, bathrobes & slippers, sheets & blankets, basic bedding, table linen and apparel. Deep inventories. Immediate Shipping.








Made In USA Signature Plus™ fabric outperforms all challengers in elegance, soft touch, color consistency and soil/stain release. American Dawn and Milliken... setting the standard of table linen excellence.




costs (including downtime), process controls, equipment/building depreciation, and more are just a few of the calculations that one must track and compare. All of this combined will provide a true picture of the operational cost of doing business, vital information for measuring success.
In looking at employee productivity, one of the best measures of efficiency for comparison purposes is a three-day best calculation. This data helps determine peak sustainable production rates and will provide a more accurate standard for performance based on best practice.
Benchmarking and performance indicators can be utilized to make comparisons between your facility and others like it. It also may help with identifying bottlenecks, therefore aiding with uptime improvement in the operation.
The key to the success of any production/performance-based facility involves the ongoing training of the employee. The expected results must be discussed with each individual, and developing operator care/ownership will encourage buy-in. Accountability of performance must be rewarded or addressed immediately, and must reflect fair practices.
Performance indicators must be realistic, but should be developed to challenge the employee to do his/her best. Following existing standards and procedures as far as “status quo” does not lend itself to the promotion of sustainable success. Continuously challenging yourself and your employees will help “sharpen the saw” and promote performance improvement.
each improvement provided me with an unnatural sense of excited accomplishment. As a “numbers driven” person, this was a perfect career position.
As time progressed, this scrutiny of daily records became more of a burden and less effective when considering time management.
Improvements in efficiencies had been achieved, and were now routine procedures. Adjusting the quality of products was, and still is, easily achieved by tweaking formulas. We understand how changes impact our profit.
The challenge we now face is retaining the trained personnel who understand the improved processes. The loss of any employee who participated in playing a part toward these improvements will have a negative effect on routine procedures and profit. New employees lack the knowledge and experience on how weights, loads, formulas, etc., impact the financials. We continue to find ways to track and measure daily, weekly, monthly and seasonal trends along with gauging employee satisfaction.
We still track and focus on those production elements I mentioned earlier. However, our main tracking element for optimum plant performance has proven to be our employees’ years of service.
how many pounds they have just washed. Purchase a floor or basket scale when using washer-extractors. CBW loading conveyors or overhead rail systems also can weigh each load.
KEEPing DATA DAiLy, wEEKLy AnD MonThLy wiLL ALLow youR oPERATion To BuDgET FoR nECEssARy EquiPMEnT, LABoR, PARTs AnD sERviCEs. iF you ARE noT TRACKing youR CuRREnT PRoDuCTion, ThEn sTART ToDAy.
Every pound counts. Just think about it: If loads are off by 100 pounds per hour, based on 365 days, assuming an 8-hour shift, that’s an astonishing 292,000 pounds per year. It all adds up.
On the finishing side of the plant, it is extremely important to set standards and track the operator’s pieces per hour. Using the above example of 3,500 pounds per hour, of which 70% is full dry, then we would need to process approximately 1,050 pounds through the ironer. This would tell us how many ironers we need or how fast we need to run the ironer to meet the production goals.
possible to detect some weak areas if you have enough reports from enough areas of your production floor. But I assume you already know about those weak areas, and records reveal how to fix them.
Production is improved by managing the process, not by checking on each individual, each hour. Sometimes managers will try to make sure all the machines are running at top speed, and yet don’t have a single worker that can work at that pace.
Blankets, towels, sheets or pillowcases each have several different sizes in the same category. Some can be processed faster than others, and if one person gets all the tough ones, that person may be perceived as slower, when that may not necessarily be the case. The more records you have, the more interpretations you have.
Production is a product of management and not a product of the worker. If workers don’t know how to do the job better, they won’t learn the better way until they are taught. And they won’t be taught until the manager arranges for that teaching. The average person has average speed, and you won’t be able to significantly increase that. The key to production is to limit the time they spend NOT doing laundry. I have lived by that rule for years.
records and, at the end of the day, your file cabinet will be full. But if your production has improved, it will be the result of your improving the process.
when I first started as a production manager, I tracked daily nearly every measurable element of production. My reasoning was that the more I understood these elements of production, the more I would be able to adjust for optimum performance in the future.
Daily tracking of each utility, pounds of soil, pounds of clean, number of loads and weight compared to washer capacity, number of loads and weight per capacity of dryer, amount of each chemical per formula used, hours of peak utilities, and the man-hours required to fold, feed and load all were analyzed daily. I became obsessed with these numbers, and
Laundry is a numbers game.
We typically process linen in pounds or pieces—usually both. It’s important to understand your cost per pound, and ultimately your pounds per operator hour. If data isn’t collected, then it is impossible to calculate the true cost.
The first thing every laundry needs to understand is how many hours it takes to process all of its linen. Once this is established, then laundry sizing and processing standards can be put in place to achieve production goals.
The laundry process is usually broken into two categories: soil linen and clean linen. I like to look at what we can wash in one hour. For example, if you can wash 3,500 pounds per hour, then you had better be able to sort, dry and fold 3,500 pounds per hour, unless you have some overhead storage capacity.
In larger CBW® plants, we like to have two hours of soil and clean storage to keep the laundry running at high efficiency. I highly recommend weighing each load processed. This practice will give you accurate data of pounds processed per load.
Too many times, employees will load a washer and try to guess
On a one-ironer plant, we typically want to finish all of the large pieces in half the shift, leaving the other half of the shift to process the pillowcase and napkins. That also means we would need to fold 2,500 pounds per hour. If you didn’t know these numbers, then you would be at risk of running overtime or even having to add an entire shift.
Keeping data daily, weekly and monthly will allow your operation to budget for necessary equipment, labor, linen, parts and services. If you are not tracking your current production, then start today. This is the only way to get headed in the right direction.
Tracking trips to the restroom or water fountain will not make your production soar. Reprimanding a worker for trips to the water fountain will make that worker begin to resent the supervisor, and that makes an unhappy worker, which in turn makes production worse.
When a worker comes to the end of a segment of work, a “natural break” such as an empty cart, completing a customer order or a jammed machine, they will go get a refreshment at that time. A manager needs to manage the process to ensure there are no “natural breaks” during the day.
Records are basically dead information. They tell you what you already have done, but give virtually no clues about how to fix the process. Determine how many productive hours were used for a period of time, and how many clean pounds were produced in that same time. Divide the pounds by the production hours, and you have pounds per hour produced. That gives you information, but not higher production.
Records and measurements are not worthy substitutes for effective management. It is




Don’t worry about correcting bad practices; instead, put your skill and knowledge into developing good practices for the production staff, and let the distasteful habits just die off. In the same vein, don’t spend undue effort forcing a worker to do something that person just can’t do. Have someone else perform that task. Assign the worker who is having difficulty to a different task. I believe in cross-training, but it is not necessary for all employees to be expert in all phases.
Consider this example of two laundry plants. Plant A is a good producer and Plant B produces rather poorly. Now swap the working crews. Plant A is still a good producer, and Plant B still produces rather poorly. The people are the same but they are working with existing processes. The workers didn’t design the process in each plant, management did. And it will take management to change the process.
You can keep all kinds of
F
rom a commercial laundry manufacturer’s perspective, meticulous equipment maintenance records are pertinent to ensuring product longevity. Although equipment upkeep isn’t a “one size fits all” operation, the suggestions here might help your recordkeeping.
Specific to multi-load washers, checking door-lock safety is simple to evaluate. Confirm the washer door can’t be opened when the machine is in operation by pulling on the door handle.
If the door opens, stop using the equipment, and call for service. If the door does not open, continue using the equipment. Regardless, note in the facility’s maintenance file the date of the test and outcome of pulling on the door.
Depending on the model of the multi-load washer, another option is to rotate the door glass and gasket once or twice a year to even the wear and counteract any “set” that the gasket tends to take over time. When and if the glass is rotated, noting the date and rotation direction (clockwise or counterclockwise) ensures the next rotation is also in the correct direction.
If the facility has rigid-mount machines, records should indicate how frequently the hold-down bolts are inspected and tightened. Hold-down bolts must be kept tight to properly transfer unbalanced forces to the floor structure. This makes for quieter machines and helps preserve the life of the tub bearings.
Cleaning multi-load washers, including the detergent box, is imperative to product longevity and should be documented.
For multi-load dryers, regular cleaning of the inside of the dryer and ductwork is important, as is washing the lint screen. Fabric softener sheets may cause a residue on the screen that can reduce airflow and affect drying times.
If dry times increase, having lintscreen cleaning documentation easily can help diagnose if cleaning the lint screen could be a possible solution.
Although not specific to equipment maintenance, it is also recommended that staff keep a daily log or notebook to note any noises, concerns or issues with commercial laundry equipment. This is extremely helpful if it becomes necessary to diagnose a future issue.
8 DECEMBER 2013 | AMERiCAn LAunDRy nEws www.AmericanLaundryNews.com
ALN Textile/uniform Rental
Peplinski Golden West Oakland, Calif.
Continued from Page 6
Tom
Experts
Commercial Laundry Richard Warren
Linen King Conway, Ark.
Equipment Manufacturing Steve Hietpas
Maytag® Commercial Laundry St. Joseph, Mich.
Equipment/ supply Distribution
Bill Bell Steiner-Atlantic Corp. Miami, Fla.



















many-flavored ice cream many-flavored American Laundry News The more flavors the better! In addition to our print edition, check out our tablet, mobile and website versions when you crave the latest industry news and updates. www.americanlaundrynews.com The Occupational Safety and Health Administration (OSHA) revised its Hazard Communication Standard (HCS) to align with the United Nations’ Globally Harmonized System of Classification and Labeling of Chemicals. Any company that produces, distributes or uses chemicals must train their employees by Dec. on the changes, reminds the Textile Care Allied Trades Association. Two significant changes contained in the revised standard, according to OSHA, require the use of new labeling elements and standardized format for Safety Data Sheets (SDS), formerly known as Material Safety Data Sheets (MSDS). The new label elements and SDS requirements will improve worker understanding of the hazards associated with the chemicals in their workplace. Training on this is needed early in the transition process since workers are already beginning to see the new labels and SDS on the chemicals in their workplace, OSHA says. There are minimum required topics for the training that must be completed by Dec. 1. Training on label elements must include information on: Type of information the employee would expect to see on the new labels, including: Product Identifier — How the hazardous chemical is identified. Signal Word — Used to indicate the relative level of severity the potential hazard on the label. There are only two signal words: “Danger” and “Warning.” Pictogram — OSHA’s required pictograms must be in the shape of square set at a point and include black hazard symbol on a white background with a red frame sufficiently wide enough to be clearly visible. OSHA has designated eight pictograms (shown) under this standard for application to a hazard category. Hazard Statement(s) Describes the nature of the hazard(s) of chemical, including, where appropriate, the degree of hazard. Precautionary Statement(s) — A phrase that describes recbe taken to minimize or prevent By Mike Schwanz NEW YORK — The 98th annual International Hotel, Motel + Restaurant Show (IHMRS) will have a different look and feel to it this fall, with new pavilions, new partnerships and new manageThis year’s show is scheduled for Saturday, Nov. 9, through Tuesday, Nov. 12, here at the Jacob K. Javits Convention Center. Following the Hospitality Leadership Forum, full day of conference and networking activities, on Nov. 9, the IHMRS will feature three days of exhibits of new products and services for hotels and foodservice properties. IHMRS is sharing some floor space with the 4th annual Boutique Design New York (BDNY), which features suppliers of high-end, unique and innovative interior design products for hospitality. The event’s new management company, Hospitality Media Group (HMG), has several changes planned. Attendees can expect a more hands-on show, with intimate, targeted networking events; on-floor education theatres; and marketplace optimistic about the current business climate. “We are very excited about this year’s show. Our new team has experience in both trade shows and hospitality,” says Show Director Phil Robinson. “We are expecting about 18,000 people this year, with about 700 exhibitors. “Like all trade shows, this one is about new products, and we feel we have many exciting new products that will be of interest to our attendees.” OcTOBer 2013 Standards developer adopts TRSA’s best management practices ALEXANDRIA, Va. — ASTM International, a global organization known for the development and delivery of international voluntary consensus standards, has published the Textile Rental Services Association (TRSA)initiated Standard Practices for Sustainable Laundry Best Management Practices recognizing the association’s criteria for Clean Green certification as universal indicators of sustainability in commercial laundry work. The ASTM standard “codifies” practices in TRSA’s Clean Green standard as “the structural, non-structural and managerial techniques” effective for a laundry to achieve green objectives, according to TRSA, adding that ASTM reviewed its standards for 19 months. The ASTM’s acceptance of the TRSA proposal reflects “our industry’s commitment to sustainability and dedication to further reducing our carbon footprint and enhancing our environmental stewardship,” says Joseph Ricci, TRSA president and CEO. “The ASTM standard, implemented through TRSA’s Clean Green certification, encourages every laundry facility to adopt sustainable, green best management practices.” Among the best management practices incorporated in the ASTM standard include conserving with a water reuse system; using environmentally friendly detergents; and filtering wastewater before discharge to sewer, among others. Late News ewspaper of ecord for Laundry Linen Management www.americanlaundrynews.com Volume 39, Enthusiasm builds for Hotel, Motel show Dec. 1 is first compliance date for newly required hazard communication training inSiDe [6] [16 Trendy Textiles must ‘keep up’ with introductions of new fabrics?” [22] Product showcase guestroom linens See IHMRS on Page 18 See HAZARD on Page 2 (File Photo: Hospitality Media Group) Goodwill Opening The nonprofit plans to process 40 million pounds annually in Miami. 1013aln_p01-02,18.FINAL.indd ▲ Mobile and Website ▼ Print Tablet The Newspaper of Record for Laundry & Linen Management
Designing an on-premises laundry room
 By Josh stEinhARDt
By Josh stEinhARDt
The design and layout of an onpremises laundry room directly impact the workflow and productivity of the laundry staff. A “perfect” laundry room benefits not only the staff and the owner/ operator, but also the cleanliness of the finished product.
Designing a laundry room with optimal workflow increases employee efficiency and decreases labor expenses, ultimately providing laundry managers with a long-term, cost-effective laundry facility.
Optimal workflow is best created when soiled linen begins processing on one side, and clean and folded are left on the other. The concept is similar to a cutting board; cross-contamination between raw meat and fresh produce is not desired. The same holds true for soiled linen coming in contact with finished, clean laundry.
The ideal laundry room also has ample space for employees to maneuver laundry carts and storage for linens. The end goal is to create a cost-effective, efficient operation. Because labor costs amount to the largest expense in an on-premises laundry, the ideal facility will require the least number of employees working for the shortest period of time.
No matter what point of the design process a laundry manager may be in, distributors and manufacturers can get involved, offering a range of services from preliminary drawing to outfitting a finalized laundry room.
Thus, there are many variables and conditions that affect how to approach a laundry room design. While there is no official first step when designing an on-premises laundry room, reputable distribu-
tors, manufacturers and architects will follow certain best-practice guidelines.
Discovering the Nature of the Laundry Facility
The general process starts with a list of questions whose answers help determine the amount and kind of laundry that will be processed at the facility.
Questions may include:
• What types of materials are being processed?
• How much laundry will be generated each day?
• How many days will laundry be generated and processed?
• How many hours each day will laundry be processed?
These basic questions help identify what processing capacity will be needed for the laundry operation. The answers likely will determine the ideal equipment mix for the operation, and identify any additional laundry equipment that may be needed.
Laundry Room Logistics
After the laundry processing capacity has been determined, laundry design experts can begin to analyze the space allocated for the laundry room.
There are two different types of design projects: refurbishing an existing laundry room, and starting from scratch, also known as a “clean sheet” project.
When working within the confines of an existing laundry room, experts need to take into account the total space available and where the laundry room is located. This information will determine what type and size of equipment can be used.
For example, if the laundry facility is located on the second floor, soft-mount washer-extractors are required. Hard-mount washer-
extractors only can be used when located on the lowest level and installed on concrete on top of hard-packed soil.
Next, the designer must determine if any equipment will be repurposed, and what utilities are currently available. The space may not be ideal because of pre-existing conditions, such as limited utilities, pillars that might interrupt employee workflow, or ceilings that may not be high enough to fit larger-capacity tumble dryers.
Working on a clean sheet project alleviates many of these infrastructure issues. “Perfect” laundry rooms do exist throughout the hotel industry; many manufacturers begin with layouts that have previously been designed effectively to create optimal workflow. When the laundry designer is a part of the project from its inception, he/she can specify that foundation, utility, room size/shape and door frames be designed to accommodate machines, and that other utility capabilities be added.
Whether for a remodel or a clean sheet, designers also need to take into consideration other potential equipment that will go in the laundry room besides washerextractors or tumble dryers.
Depending on the industry (hospitality, healthcare, etc.) or the requirements of the operation itself, many items come into play: folding tables, ironers, laundry carts, soak sinks, storage racks and more.
New Technology
To help plan for all of the necessary equipment, some manufacturers utilize advanced software systems that provide layouts of the laundry room based on the facility’s current building specifications. Some systems even allow
the perfect laundry room has an optimal workflow and cuts down on labor costs and increases efficiency by helping ensure that the equipment is continually in operation, with little downtime.
A laundry room cannot run at maximum efficiency if employees have a hard time using the equipment properly. Employees have the potential to get injured due to overexertion in an unsafe or inconvenient work environment.
the customer to see his or her future laundry room with 3-D renderings. These renderings offer the on-premises laundry manager a better feel for the size and spatial layout of the room. The design can then be tweaked based on the manager’s feedback.

Special Considerations
Laundry design experts must also be mindful of human requirements and local regulations. Staff requirements to consider include personal safety, a layout that doesn’t require overreaching for equipment, or overexertion, and ease of use. As previously stated,
Laundry designers must also adhere to local regulations. For example, if a fire suppression system is mandated within the laundry facility, designers need to know exactly where sprinkler heads are placed. Once aware, designers will make sure they do not place a dryer directly beneath the sprinkler so the heat does not set off the system.
As with any construction project, achieving the perfect laundry room takes time and the support of a knowledgeable team. Consider working with a partner that can help guide and design an onpremises laundry room with the ideal workflow. ALN
Josh Steinhardt is a regional sales manager for UniMac®, a manufacturer of on-premises laundry equipment. He can be reached by e-mail at josh. steinhardt@alliancels. com or by phone at 920748-3121.

10 DECEMBER 2013 | AMERiCAn LAunDRy nEws www.AmericanLaundryNews.com
OPL 101
Creating laundry with optimal workflow boosts employee efficiency while cutting expenses
Steinhardt
stAff REquiREMEnts to ConsiDER inCLuDE pERsonAL sAfEty, AnD A LAyout thAt DoEsn’t REquiRE EMpLoyEEs to ovERREACh foR EquipMEnt.
The laundry room should have ample space for employees to maneuver carts. (Image: UniMac)
Ideally, the laundry designer will be involved with all elements of a project from its inception, UniMac’s Josh Steinhardt says (Image: UniMac)
In establishing a program, Corfield also stressed the importance of matching staff to roles that best suit their aptitude.
“It’s always going to be important that we pick the right people to do the right types of work,” he says. “As you’re building and designing your programs, I think it’s important to really stop and look at your team members.”
Performance Metrics
In general terms, Corfield then advises managers to develop and implement metrics to help the company save and protect its resources, among them locally driven safety programs.

“What you want to do is avoid and prevent accidents. In this case … safety has a huge impact on finances, as well as the fact that it protects our most important resource, which is our people.”
He also highlighted the importance of workstation assessments to not only improve productivity in workspaces, but to also mitigate worker fatigue and stress. Another aspect, utility optimization, enables managers to evaluate the cost of energy and other resources workers use at workstations, according to Corfield.
Another performance metric is evaluating the quality of items processed. “Improved quality is something that different organizations look at in different ways,” says Corfield. “Sometimes it’s compliance with healthcare standards, or sometimes it’s customerdriven around the expectation of the look of the delivered product.”
Adhering to a quality metric then leads to customer retention programs, according to Corfield. “At almost every step in the process of laundering … look at programs that are directly related to … the customer so that we can understand how to best meet the needs of the service’s end-users,” he says. “You really need to get your team invested in the company performance measurement, and be consistent about this.”
Translate Metrics to Processes
One of the ways managers can coach staff in utilizing these metrics is reporting things like process issues and machinery issues, such as water drain leaks.
“Even though engineering may be the primary driver around that, it really takes the day-to-day workers to look at that, and then the managers need to help them understand what the impacts of those are,” he says. “Building metrics around that [and] reporting on those metrics may be a way to get everyone involved in helping maintain the plant.”
Corfield also encourages managers to coach drivers into utilizing metrics that can gauge feedback
on customer-related issues, such as damage, loss issues, and inventory quota problems. “Drivers, anybody who’s actually delivering linen to a unit might be the best source of information to help you understand how you’re doing.”
Stating the value of the delivered linens to the end-user and to the driver also helps from a monetary savings standpoint. “They now have a dollar value attached to it, so now the end-user [understands] monetary value, and the drivers [understand] that they’re helping the organization save money through helping [customers] understand and evaluate value
[for] that linen on the unit level,” he says.
One other metric managers can adapt to their laundry is having workers report on textile linen problems related to quality and longevity, says Corfield. “Notice if there’s a new product that’s been introduced … Coach your team so they understand what may be occurring with a particular textile,” like fraying or heat damage. “Help them understand … what that quality means.”
Coaching staff to evaluate their processes can greatly impact overall workflow production. “These are opportunities that you can
look for throughout your organization,” says Corfield. “Identify what your program goals are, measure [them] correctly, and then go find opportunities.”
Allow for Review and Feedback
“Sometimes organizations get a little stuck at doing what they’ve always done,” says Corfield. “But sometimes there are better opportunities in the way to approach and do certain types of work.”
Through this viewpoint, Corfield stressed the importance of coaching staff to adapt to changes. “You need to constantly evalu-
ate your programs and then look at the assets that are critical for your success,” he says. “I think it’s important that you have to look at this element of your program to really understand where you’ve been, what you’ve been doing … and then where you want to go.”
He adds that collecting feedback on processes is key to helping staff understand the “context of their activities,” and that the simplest way to collect feedback is what can work best.
“Not every team has a winning season. It’s as important to talk about bad news as it is about good news, and learn from that.” ALN
www.AmericanLaundryNews.com AmericAn LAundry news | decem B er 2013 11
PROJECT MANAGEMENT BECAUSE YOUR BUSINESS NEEDS ARE UNIQUE! Who We Are: A Team of Engineers, Process and Operations Veterans, CAD Artists, Sales Professionals, and Office Support Staff. What We Do: Plant Assessment Consultation Building Design Services Equipment Solutions Installation Services Our goal is to ensure that equipment installations go smoothly and are properly executed on time and on budget! Redefining Customer Satisfaction! Proudly Made in the USA | ISO 9001 Certified (800) 432-7286 | gabraun.com BraunProjectMan Ad 11/6/13 9:21 AM Page 1 ALN_Jr Page.indd 1 11/7/13 10:22 AM coaching continued from Page 1
Before a brand-new or retrofitted laundry plant goes online, there can be months, even years, of project preparation.
As a way to recognize all the hard work that goes into designing, building and equipping a modern laundry plant, American Laundry News created this Designing Success feature to spotlight portraits of memorable plant installations. Here, institutional/on-premises, commercial and industrial laundry equipment manufacturers, plus firms that offer design-build, engineering and mechanical contracting services, tout their thought-provoking projects of the past two years.

Halawa Correctional, Aiea, Honolulu, Hawaii, is the largest prison facility in the state of Hawaii’s prison system. Operated by the Hawaii Department of Public Safety, Halawa Correctional houses approximately 1,500 inmates in two facilities: a special-needs facility and a medium-security facility. The main laundry serves the prison system’s population with the throughput capacity to produce 2 million pounds of laundry per year.
The facility was searching for technology that would limit water consumption yet maximize washroom capacity within the boundaries of the existing space limitations at Halawa Correctional. EDRO Corp. was able to partner with a utility consultant and combine its ozone-powered washer-extractors with a water treatment system to reuse wash water and limit sewer discharge.
To maximize wash capacity per square foot, EDRO utilized its “ER” washer-extractor option, the company says. The “ER” variant reverses the positioning of electrical components and mirrors door-swing operation. This allows the placement of equipment adjacent to structures that would impede normal machine operation. By utilizing this option, the facility increased its washer throughput capacity by 50% in the same space.


Taking six months of work from start to finish, the installation was a main laundry upgrade project, including site design, removal of existing machinery, upgrade drain pit and foundation, and installation of new machines with upgrading of utility resources.
Kannegiesser USA, for Ecotex Healthcare Linen Service






























Seattle-based Ecotex Healthcare Linen Service is a family-owned and -operated healthcare linen services company, serving the Western and Southwestern United States as well as Canada.






Having been in the laundry industry since the 1970s, Ecotex has proven experience and focuses on constantly improving its operations and levels of customer service. This particular commitment to the customer has made Ecotex extremely competitive, and allowed the company to grow its business. Its production facilities carry HLAC accreditation, and are certified both “Clean Green” and “Hygienically Clean Healthcare” by TRSA.
Ecotex recently installed a new Kannegiesser Tunnel Washing System in its 40,000-square-foot Albuquerque, N.M., facility, which processes hygienically clean healthcare linen for hospitals in New Mexico and the West Texas region.
Based on the strategy of relocating older capital equipment to its other laundry facilities, Ecotex planned on investing in a new wash system for Albuquerque, with the goal to increase production capacity and improve processing quality. The company issued a formal RFP process for the bid in October 2012. Following intensive review and due diligence, Kannegiesser USA was awarded this project in early December 2012.
The Kannegiesser design team and Ecotex management worked collaboratively to develop an effective plan to install the new system—customdesigned and built in Kannegiesser’s factories in Germany—next to the existing system, which was being replaced. It allowed Ecotex to continue using its tunnel system as long as possible, while preparing the utility connections for the new Kannegiesser equipment.
a replacement shipment “off the shelf.” However, the Kannegiesser factory realized the necessity for a high-priority production slot, and rearranged the existing schedule to place the Ecotex replacement machine on a fast track.
As the replacement tunnel was being manufactured, installation of all other pieces of the system continued. The Lowden independent rigging company utilized the time to place the equipment based on the approved design layout. Meanwhile, the Kannegiesser technicians, working with local utility contractors, installed as much of the mechanical setup as possible, which enabled the replacement tunnel to be installed with a minimum delay when it finally arrived on-site.
“We went into this project with high expectations,” says Bryan Bartsch, Ecotex vice president and director of operations. “Despite the challenges with the highway incident, the Kannegiesser team rallied to create a successful installation.”

The effort by the Kannegiesser factory team cut several weeks from the standard manufacturing timeframe. The replacement tunnel arrived in Albuquerque less than three months later, and was commissioned in September.
Ecotex indicates that its Albuquerque plant is now on track to process more than its previous
EDRO manufactured and supplied one DW300SMDOS (a 300-pound endloading washer-extractor), one DW300SMER-DOS (a 300-pound end-loading washer-extractor with “ER” option), and one CSL110 (a 110-pound open-pocket softmount washer-extractor).

DOS (a 300-pound endmount washer-extractor).







Additionally, the chemical vendor for Ecotex was brought in early in the process to discuss the new PowerTrans PLUS™ technology, and how the system setup offered many options to achieve top wash results.
The new DynaWash washer-extractors were fitted with inverters and single motor drives, an upgrade to the older multi-motor-drive set-up of the facility’s existing machines. Inverter with single-motor-drive technology is a tremendous advance in machine speed control and greatly reduced peak electrical load demand, EDRO says. This motor design has significantly fewer parts than a conventional multiple motor setup with single-speed motors, clutches and gearboxes, while delivering more speed selections and greater energy efficiency, the company adds.
ted with inverters and single
The system components installed by Ecotex include a pocket load conveyor (PB 4-85), 187-pound batch size tunnel washer (PT+85-12), hydraulic press extractor (PP 10-85-56 Turbo), intermediate conveyor, lift shuttle conveyor (LSC-9 & SPS controls), seven gas-heated system single batch dryers (D 85 G-WU), bypass conveyor (no dry station), central lint collector, and OSHA-approved safety fencing.
Coupled with the programmability of the HMi/PLC, EDRO’s washer-extractors can deliver exacting cylinder RPMs for top wash results from wash speeds through high extract. Multiple parameter settings allow high-torque wash speeds with steep slope starts and stops, and elongated slopes for even load distribution and acceleration to high extract, EDRO says.
The High Slip Braking feature allows for braking torque in excess of 100% of fullload motor torque by controlling the deceleration from high speed to make the motor operate as a highly efficient induction generator.
Through the energy consultant, Halawa Correctional was able to apply for utility rebates to assist in the funding for the new washers. EDRO also designed the wash aisle layout, oversaw machine installation, and provided start-up and training.
Client benefits include increased wash capacity from the same machinery footprint, lower wastewater discharge into the State of Hawaii public sewer system, and better utility utilization of water savings and electrical consumption, EDRO says.
Partnering with US Joiner and Noresco for installation and consultation, the Halawa Correctional Facility main laundry upgrade project cost $350,000. ■
The new equipment was on track for on-time delivery. All the containers arrived at the port of Houston and cleared U.S. Customs on schedule. They were then placed on independent trucks for the 900-mile journey to Albuquerque. On May 11, one of the flatbed trucks traveling through Texas encountered a severe rainstorm. The driver lost control of his vehicle, which was carrying the main tunnel washer structure. The truck flipped onto its side, totaling the new Kannegiesser tunnel onboard. Fortunately, the driver was not injured, and no other vehicles or equipment were involved in the crash.
As each tunnel is customized to the specific customer application, there was no possible way for



goal of 14 million pounds annually, based on the needs of its customers and the preferred operational production shifts. The company has been able to reduce its previous 16-hour-per-day work schedule in the washroom to a planned 10-hour daily schedule utilizing the new Kannegiesser system. Initial goals of washroom labor reduction and utility savings overall have been achieved, and customer feedback regarding linen quality has been encouraging.
“The performance of the Kannegiesser system has, so far, surpassed our expectations,” says Ecotex President and CEO Randy Bartsch. “We are impressed by the improved brightness and whiteness of the linen we are producing.” ■


12 DECEMBER 2013 | AMERICAN LAUNDRY NEWS www.AmericanLaundryNews.com
EDRO Corp., for Halawa Correctional
Kannegiesser had to fast-track a second tunnel washer (above) when the first was destroyed (below) in a traffic accident while en route to Ecotex.
Booth Centennial Healthcare Linen Service (BCHLS), Mississauga, Ontario, Canada, is owned by its member hospitals. They serve 120 healthcare facilities, of which 40 are senior care facilities.









The organization was using old, inefficient machines and decided that it needed new equipment. Therefore, Booth executives decided to install new, energy-efficient Electrolux Professional laundry equipment to save water and energy, plus boost productivity. Ontario Laundry Systems, a distributor also based in Mississauga, was hired to oversee installation and to service the new equipment.
The 300,000-square-foot facility offered a good amount of space. Electrolux Professional washers

with AWS (Automatic Water Savings), which reportedly saves Booth Centennial up to 40% in water. With each wash cycle, AWS determines load weight and adds precisely the right amount of water, resulting in reduced water consumption and energy costs. AWS communicates directly with a Softrol computer network, reducing the volume of chemical injection to match the load and water volume for precise concentrations. This extends linen life by eliminating excessive chemical exposure, and adds up to lower costs, lower detergent consumption, and a superior wash.
The machines also use new Compass Pro technology for easy programming. Booth can program the washers so that operators see only the programs they use, reducing human error and increasing productivity.
Other features include Residual Moisture Control (RMC), which prevents damage to linens caused by overdrying, and reduces lint and wrinkles by automatically stopping the dryer when the exact pre-set moisture level is reached.

Electrolux dryers come standard with reversing dryer cylinders – another time and energy saver. The reversing action improves dryer efficiency and minimizes tangling and wrinkling.
B&C Technologies recently partnered with Southern Vacation Rentals to renovate its laundry. Southern Vacation Rentals represents more than 900 short-term and 750 long-term rentals, 30 associations and countless real estate properties. It services the laundry needs of condominiums in the panhandle of Florida, with a 2,000-square-foot laundry processing center located in Destin, Fla.
The laundry could not process goods efficiently; its energy consumption and maintenance costs were too high, and the company did not have any folding equipment, B&C reports. After an increase in demand, company executives decided to streamline the laundry and convert to a B&C plant.



The laundry equipment was removed and the room remodeled with new paint, flooring and ceiling. An inventory area was added.
B&C assisted with layout design (Mike Murphy of Greenwood Marketing and Design provided laundry layout design services), calculated machine needs and oversaw installation. The installation also led to a new dirty-to-clean workflow.
and dryers were installed in a special area called the COG (customerowned goods) room, where BCHLS processes personal clothing for residents of long-term care facilities, as well as hospital curtains, uniforms, mattress liners and other healthcare laundry from their hospital clients. It’s also ready and able to handle regular linens, and serves as a backup for that.
Electrolux Professional washers come standard


























Electrolux Professional laundry equipment installed new or replaced as part of the BCHLS project included four 135-pound washer-extractors, two 65-pound washers, four 135-pound dryers and two 83-pound dryers. Once the project was completed, Booth Centennial began benefitting from savings in time, water and energy. The facility can process more than 90 million pounds of critical healthcare laundry annually.
replaced part of the BCHLS project included four 135-pound was completed, Booth water and energy. The facility can process more than



Laundrylux, which supplied the information upon which this article is based, distributes Electrolux Professional and Wascomat commercial laundry equipment through an extensive North American distributor network. ■
Removal of equipment and the facility renovation took approximately four months. Installation of new equipment and startup took one week. At press time, Southern Vacation Rentals had processed 715,000 pounds in 2013.
“Everything was installed in January this year, and we have already seen a reduction of 50% in employee as well as energy savings,” says Chief Operating Officer Marie Babin.
Three SP-100 and two SP-60 soft-mount washer-extractors replaced five hardmount machines; the SP Series features high-speed 350-G extraction, energy efficiency and minimum maintenance, B&C says.

Three DE-120 and two DE-75 high-efficiency dryers with humidity sensing were installed. The feature automatically stops the dryer when goods are dry.
Also installed were a sheet folder with stacker and the new sorting PF-3 Professional Folder. The folding equipment has allowed Southern Vacation Rentals to significantly reduce staff and increase production, B&C says.

Project cost, including facility remodeling and equipment purchase, was around $270,000.
■















The new Best Western Premier Waterfront Hotel & Convention Center (The Waterfront), in Oshkosh, Wis., offers 176 rooms, 5,000 square feet of function space, 18,000 square feet of convention space, and the Ground Round at River’s Edge restaurant. It also boasts a Girbau Industrial on-premises laundry capable of processing 2,400 pounds of laundry in a single eight-hour shift.
The property, which had operated under many hotel brands since the 1980s, was nonfunctioning prior to its rebirth in May. The Waterfront required $13 million in renovations, according to General Manager Dan Schetter.

Girbau Industrial (GI) designed and equipped the inhouse laundry for automation, productivity and efficiency. All laundry is processed in-house for total control over the quality and availability of food-and-beverage skirting, tablecloths and napkins; sheets, pillowcases and duvets; towels, bathmats and robes; pillows, comforters and blankets; and rags, mops and rugs.
“The laundry’s equipment mix offers automation and high-quality finishing and folding,” adds GI National Sales Manager Seth Willer. It includes three 90-pound-capacity Continental Girbau soft-mount E-Series washer-extractors and a 120-pound-capacity dryer, as well as a GI 140-poundcapacity ST-1300 dryer with vacuum load. Towels, bathmats and blankets are automatically folded using a GI FT-LITE drywork folder, while sheets, pillowcases and tablecloths are processed using a GI 5-in-One Compact
Ironing System. The Compact – a feeder, ironer, folder, stacker and accumulator – processes up to 82 feet of linen per minute, GI says.
“I came from another property with 95 rooms,” says Housekeeping Manager Misty Braun. “When it was sold out, it took three eight-hour shifts and three operators per shift just to get the towels and linens done. Laundry would spill over from Sunday to Monday. Here, when we are sold out, we have five operators on for eight hours. Yet we have triple the rooms and process foodand-beverage items in addition to regular laundry. We are saving a lot on labor as a result of the automation.”
The laundry’s programmable E-Series washers properly clean a variety of items, feature a soft-mount design for simple installation, and reach extract speeds of up to 381 G-force. They automatically combine the correct chemicals, water temperatures and levels, mechanical action and baths to ensure high-quality results.
A 90-pound load of towels takes just 50 minutes to wash and 19 minutes to dry using the ST-1300 Dryer, according to Braun. Meanwhile, the Compact feeds, irons, folds and stacks more than 120 sheets per hour—straight
from the washer. The ST-1300 dryer, with vacuum loading, “inhales” items fed by operators. Once dried and automatically unloaded, terry
items and blankets are fed into the FT-LITE folder.
items kets the FT-LITE folder.
All flatwork items – sheets, tablecloths, table skirting and pillowcases – are fed directly from the washer into the Compact, where they are ironed, folded and stacked.
















Equipped to handle the hotel’s growing sales volume, The Waterfront’s laundry ensures a high-quality product for hotel guests, according to Schetter. “It allows us more control over linen inventory and quality, and over time, it will save us significantly in outside vendor costs.” ■

www.AmericanLaundryNews.com AMERICAN LAUNDRY NEWS | DECEMBER 2013 13
items – sheets, tablecloths, Girbau Industrial, for Best Western Premier Waterfront Hotel & Convention Center
Electrolux Professional, for Booth Centennial Healthcare Linen Service B&C Technologies, for Southern Vacation Rentals
Maytag Commercial Laundry, for Shriners Hospitals for Children®


Following a recent transition from a 30-bed acute-care hospital to an outpatient facility, Shriners Hospitals for Children® – Erie (Pa.) Ambulatory Surgery Center and Outpatient Specialty Care Center was looking for ways to green its operations.

The facility now has a four-day-a-week laundry operation, which cleans approximately 3,400 pounds a month, consisting of towels, sheets, surgical scrubs, cubicle curtains and blankets.
The main obstacle standing in the way of a greener laundry was an older, 135-pound washer. When coupled with a Maytag® Commercial Laundry 50-pound washer-extractor installed at the facility eight years ago, the less-efficient 135pound washer had become excessive. This led to inefficient use of staff labor hours, as well as unnecessary energy and water costs. The solution to this dilemma was twofold— installing new, energy- and water-efficient equipment to make the facility greener and reduce utility costs, and ensuring that the new equipment was the proper size to meet current laundry needs.
“We’re trying to be more energy- and water-efficient these days, and running more correct-sized loads is a smart decision,” says Laurie Bowe, CHESP, manager of environmental services for Shriners Hospitals for Children. “It was difficult for us to operate as efficiently as possible, in regards to staff hours and energy and water consumption, using older, oversized laundry equipment. With the change in facility services,
we saw an excellent opportunity to upgrade to new, appropriately sized laundry equipment that would better meet our needs.”
Bowe and her team connected with veteran Maytag distributor Equipment Marketers. The Cherry Hill, N.J., company presented them with energy- and water-saving equipment options appropriate to the size of the hospital’s laundry operations. This ultimately led the hospital to its second Maytag Commercial Laundry Energy Advantage™ 55-pound Soft-Mount Washer-Extractor.
“The team at Equipment Marketers was personable and well versed in product options, our application and the needs of our facility,” Bowe says. “They provided us with all of the information we needed to make the best equipment decision for our facility.”
Equipment Marketers also discussed installation requirements and the flexibility offered with Maytag equipment.
The 55-pound Soft-Mount Washer-Extractor model is designed to fit through a standard 36-inch opening. The softmount suspension system reduces the need for machine boltdown, so installation is possible on above-grade floors. The 304-grade stainless steel cabinet is tough enough to withstand ongoing use.
“There was no downtime with the installation of the new equipment, which is so important to our type of facility, which needs clean linens available at all times,” Bowe says.
“Being environmentally conscious and finding new ways to operate more efficiently and within budget is crucial in


Jensen USA, for Hospital Central Services Association

Hospital Central Services Association (HCSA) recently commissioned a new, ground-up cooperative healthcare laundry covering 144,000 square feet. The facility built in the Seattle suburb of Auburn, Wash., is owned by five local hospitals.

The previous laundry, located in downtown Seattle, resided in a building built in the early 1900s and until the 1960s was home to a bread factory. Its size required the laundry to operate approximately 100 hours per week to produce the required poundage, forcing the organization to turn down potential customers despite its ability to produce high-quality linens and uniforms.
But the downtown site made it desirable, simplying its sale to help justify the move to a much larger, energy-efficient building. The degree of innovation in the new laundry can be considered impressive, from a full reverse osmosis water treatment system, to the Senking Universal
Jensen provided the principal equipment recommendations for the batch tunnel systems, flatwork finishing equipment and clean-side automated rail system. Its design staff worked closely with the HCSA staff, and prepared multiple AutoCAD layouts before a selection was made. Its Engineering Department reviewed and made changes to proposed equipment built specifically for HCSA.
Jensen’s management team was highly involved with HCSA’s project management, as well as all the trade companies involved in planning and executing the project. Scott Clark was retained early in the project’s conception, and then later as HCSA’s project manager.
Work started in September 2012 and was completed in July 2013. The seventh-coldest and wettest winter on record in the Seattle area caused several delays due to deep mud, drainage concerns and concrete-pouring complications, but the project was completed on schedule despite it all.
the laundry rooms of today’s healthcare facilities,” says Bob English, general manager at Maytag Commercial Laundry. “Upgrading to appropriately sized, multi-load high-speed washer-extractors allows more laundry to be done in less time and increases staff efficiency.”
Since installing the second washer-extractor, the hospital has seen positive results.
“Our laundry facility is now optimally sized, and we’ve seen further reductions in energy and water consumption reflected in our utility bills,” Bowe says. ■
In early 2011, Susan Witcher and her team at Kansas City-based Faultless Linen approached American Laundry Systems (ALS). Faultless’ healthcare operation in the area was continuing to expand, and the company planned to build a new healthcare processing laundry plant in St. Louis.














Faultless hired ALS for complete design-and-build services, which included complete laundry design, equipment and construction RFP services, equipment installation, mechanical process piping, and overall project supervision and management.
A key design feature is that it can handle both bulk healthcare and medical retail accounts under one roof, maximizing return on investment and providing the most flexibility for future growth.
Universal bler/dryers; two Jensen Express corner-























































batch washing system’s water reuse system, to the flatwork ironer heat reclamation used to preheat the warehouse space.

HCSA’s planning time was approximately five years to build a new automated, high-production, high-quality laundry. Its board of directors approved the project in 2012, and HCSA prepared and distributed an RFP for equipment considerations. Jensen USA was awarded the project in late summer 2012.
HCSA purchased all-new equipment, with the exception of a couple relocated items. The package included two Jensen Senking Universal Maxiline 250-pound, 12-module batch washers; two Jensen Senking SEP120SEP 57-bar extraction presses; 16 Jensen Senking DT140 single-batch tumbler/dryers with central lint system; three Jensen DTX450, 450-pound stand-alone tumbler/dryers; two Jensen Express cornerless 2-station large piece spreader/feeders; five Jensen EX12 48-inch 3-roll steam heated flatwork ironers; five Jensen Classic S large-piece folder/crossfolders with dual sorting stackers and conveyors; a JENSEN Bottom-Up Stacker for ironed small-piece accumulation and stacking; a Jensen Classic Blanket folder/crossfolder with stacker and conveyor; two Jensen Tematic Pro small-piece folders; and a Jensen Futurail complete automated clean-linen storage and delivery system. Currently, the laundry processes 20 million pounds annually operating six days per week, with the capability of expanding up to 30 million pounds without adding hours. The laundry design has pre-planned for expansion up to 48 million pounds a year by adding processing equipment only.


With new paint, upgrades of plant lighting and diamond polish of the floor, a 100,000-square-foot building was made to look brand-new. Existing gas service was upgraded to accommodate laundry needs. Some of the offices were retrofitted to make a new employee cafeteria/break room while others were upgraded to house the Faultless management team. Local company HDB Construction completed all of the building-related work.
heated flatwork ironers; five Jensen Classic S large-piece folder/crossfolders sorting small-piece accumulation and stacking; a Tematic Pro small-piece folders; and

The ALS/Faultless design team decided to go with Milnor washroom equipment (accompanied by a Kemco process water system) and Chicago Dryer Co. finishing equipment. E-Tech supplied the materialhandling system. Softrol supplied the semiautomated garment sorting system. A custom-built cart washer was designed by Automation Dynamics, with input from the ALS/Faultless team.
All the equipment installation, process mechanical piping, equipment ductwork and final connection work was done by ALS. The mechanical process piping, such as city cold water, hot water, tempered water, natural gas and compressed air, was designed to handle future plant growth and addition of equipment. Electrical services were upgraded and designed so that future equipment can easily be installed and brought online without any major disruption to plant operations.
The entire process, from building construction to equipment installation and final commissioning, lasted approximately six to eight months. The new plant has total capacity to process 43 million pounds of healthcare /medical retail laundry annually; it was processing approximately 18 million pounds annually in serving 20-plus hospitals and more than 400 medical retail customers at the start of 2012, ALS says. ■
14 DECEMBER 2013 | AMERICAN LAUNDRY NEWS www.AmericanLaundryNews.com
■
American Laundry Systems, for Faultless Linen
Chicago Dryer Co., Milnor, and
























After nearly 50 years of processing linen for healthcare facilities in and around the Orlando area, Florida Hospital Laundry’s (FHL) 27,000-square-foot facility could no longer process cost-effectively.

In July, FHL opened a new, 64,000-square-foot, state-of-the-art laundry facility just 200 yards from the old plant in Seminole County. The new plant is designed to process 50 million pounds of linen per year operating two shifts, six days per week. The project took approximately 18 months from design to completion, with construction taking about 10 months. FHL director Marvin Burske, and the late James Skidmore, his assistant director, led the design phase.
FHL hired Turn-Key Industrial Engineering Services. Its president, Chip Malboeuf, led the project, working collaboratively with the FHL
Hospital Laundry
Turn-Key Industrial Engineering Services, for Florida







Environmental Solutions (IES). Hardin Construction and RLF Architect built the facility.

The goal was to get the new facility running prior to relocating some existing equipment from the old location. Commercial Installations, owned by James Everett, skillfully rigged in new equipment and relocated existing equipment without interrupting services to the hospital customers.
The E-Tech soil-sort system is designed to handle the facility’s healthcare mix at roughly 10,000 pounds per hour, sending full 150-pound slings to Milnor continuous batch washers and washerextractors. The wash system is comprised of two 12-module CBW® washers with PulseFlow® EXD (EXtreme Dilution) Technology.

With the Milnor/E-Tech Press-to-Bag-to-Dryer material-handling configuration, Milnor’s Dryer Pod design eliminates the need for shuttles and prevents bottlenecks. The E-Tech Clean Rail System delivers post-dry goods to the Chicago® finishing systems or directly to the Chicago flatwork ironer department.
ARCO/Murray National Construction Co., for Goodwill Industries of South Florida



The Laundry Division of ARCO/Murray National Construction Co. retrofitted an old, dark, dirty warehouse building built in 1957 to accommodate Goodwill Industries of South Florida’s new healthcare plant ion Miami (featured in October’s American Laundry News). Much of the structure had to be gutted and renovated.
Usable space had to be increased to maximize production capacity. The truck dock area at front was filled in to increase the soil and clean dock staging areas, and part of the rail dock area in the rear was filled and a new mechanical room constructed. The remaining dock area was incorporated into the press-to-rail system design as a pit area for loading slings. A new 4-inch-thick floor slab was poured over existing slab and diamond-polished to improve the aesthetic look, increase light reflectivity, and minimize floor maintenance.
team and TurnKey’s stable of consultants and engineers to develop options.
Once FHL chose a high-level conceptual design, Turn-Key assisted with site and building selection; designing the production space, including building and equipment layout; developing budgets and opinions of probable cost; developing RFPs for equipment; assisting FHL in analyzing RFP responses and making equipment selection; and working as project managers through the completion of construction, equipment commissioning and plant start-up.
Distributor Steiner-Atlantic Corp. was the primary equipment vendor; its manufacturing partners were Chicago Dryer Co., Pellerin Milnor, E-Tech, Energenics Corp. and Integrated


heated ironers relocated from the older facility. The towel
machine are a mixture of the Air Chicago and Air Chicago Blaster Systems, one Chicago Skyline
Flatwork equipment consists of four complete Chicago chest ironer lines. Two utilize Powerhouse 2-roll, 5200 self-contained gas-heated ironers with Edge Maxx cornerless feeders and Skyline sheet folders. The remaining lines use Century 2-roll, 5200 steamheated ironers relocated from the older facility. The towel folders and isolation gown machine are a mixture of the Air Chicago and Air Chicago Express. There also are two Chicago Blanket Blaster Systems, one Chicago Skyline Mini and three Chicago Flippers for washcloths.
The new feeders and folders have the state-ofthe-art CHI•Touch touch-screen processor.
Energenics provided a double Kartwash, a fully automated and programmable cart washer with the ability to process up to 75 carts an hour.

Twenty-four IES SonicAire fans were installed to assist in removing lint buildup on rafters.

Because the entire floor was raised 4 inches, all exterior doors and frames had to be raised, too. Metal panels replaced fiberglass wall panels to improve structural integrity and eliminate potential security issues. A new mechanical room, maintenance rooms, soil/ clean separation wall, pack room, soil-side restrooms, and a decontamination room were constructed within the interior. All floor trenches, pits, floor drains and thickened foundations were installed to match up with the new laundry production equipment.
The building’s interior and exterior were painted white and light gray to make it clean and bright, and new high-efficiency interior lighting was installed to increase light levels in the plant, improving the work environment.


A new ventilation system was installed to improve the building airflow, and spot cooling was provided at employee workstations. A new ramp was installed and restrooms constructed to provide proper access for those with disabilities.
All main utilities were upgraded to ensure that water, sewer and electrical capacity would be sufficient now and in the future. The process piping, ductwork and electrical systems were installed and final connections were made to the laundry equipment to ensure each piece could produce at maximum productivity and efficiency. Finally, the office was completely gutted and rebuilt.
“This was not your typical laundry retrofit where you find a nice, new warehouse and install some laundry equipment,” says Ed Kwasnick, director of business development for Turn-Key. “It needed a lot of help at all levels. In fact, other companies might have found it easier to demolish the existing structure and build new.”
But Goodwill’s mission is about helping people reclaim their lives through the power of work, and it took the same approach in repurposing this building, he says. ■
■












“It has been exciting to see this project come together,” Burske says. “We have faced many obstacles, including sorrow and sadness, but through it all, everyone—contractors, vendors and employees—pulled together to deliver a beautiful facility,” he says.

www.AmericanLaundryNews.com AMERICAN LAUNDRY NEWS | DECEMBER 2013 15 ALN_Tab_1-4_H.indd 1 7/16/13 3:58 PM
ANDERSON CHEMICAL CO.
The INTEGRA System® is Anderson Chemical Co.’s patented chemical staging and delivery technology. It is a systemby-system approach for handling laundry, kitchen and housekeeping cleaning fashioned around a single concept — utilizing wall-mounted holders containing super-concentrated liquid chemistry in inverted 1-gallon capsules.
Each capsule contains a SurSeal valve that is opened only when placed into the INTEGRA® holder or Activator. This closed system allows the liquid to flow safely into an 8-ounce reservoir from which it is pumped to the cleaning device, the company says. Once the inverted capsule is empty, the operator still has an 8-ounce reserve to keep operations going.
Concentrated products allow the systems to be cost-effective. Product formulas are flexible enough to be used in a three-, four- or five-pump system for all soil levels and water conditions.
The INTEGRA Program® offers both conventional and Design for the Environment (DfE)recognized products.
www.accomn.com 800-366-2477
DIAMOND CHEMICAL CO.
Diamond Chemical Co. recently introduced a low pH-oxidizing agent, Diamond Brite™.
Diamond Brite is an oxygentype bleaching agent that helps a laundry lower costs by reducing water usage and temperature. The product helps reduce stains and rejects, and lowers the amount of total dissolved solids, helping deliver a softer finish. It also helps to lower alkali use and pH washing.
DETERGENTS, CHEMICALS & INJECTION SYSTEMS
DETERGENTS, CHEMICALS & INJECTION SYSTEMS


The company says Diamond Brite™ is safe on colors while creating a gentler washing environment.
www.diamondchem.com 800-654-7627
TEAM SYSTEMS
Magnum Power, from Team Systems, is an environmentally safe, biodegradable, nonstaining and easily dispersed heavy-duty degreaser, says the company.
Magnum Power has emulsifiers designed to remove most stains found in the hospitality laundry industry, and it can be used in spot treatments and stain loads.
The degreaser is effective against make-up and shoe polish, and it is safe on most fabrics and linens, the company says.
www.teamsystemsinc.com 800-652-0717
EDMAR CHEMICAL CO.
BACSTOP™ is a concentrated, ready-to-use liquid fabric sanitizer from Edmar Chemical Co. Used in the final rinse, BACSTOP offers a sanitizing and bacteriostatic finish. Under conditions of contamination, the sanitizer kills 99.9% of infectious bacteria.
Unlike bleach, which stops working after textiles are removed from the wash-wheel, BACSTOP remains active on the textile surface, Edmar Chemical says, helping to aid in the prevention of cross-contamination from gram-negative bacteria (i.e. Klebsiella pneumoniae) and
ties, hospitality laundries, military facilities and prisons. www.edmarchem.com 440-247-9560

M&M TECHNOLOGIES
Used in the wash process, PROTEX 2000® Fluid Repellent from M&M Technologies reportedly renews and maintains the repellency of barrier fabrics used in surgical gowns, isolation gowns, wraps and drapes.
It helps to reduce staining and protect the healthcare provider. The product also benefits hospitality linens.
The company’s latest version, PROTEX 2000®-GR Fluid Repellent, works the same way as the original, according to the company, and is more efficient and environmentally friendly.
The loss of the original repellent finish on surgical gowns and most surgical linens can result in staining. PROTEX is the same finish altered slightly so it can be reapplied in the laundry process. www.fluidrepellent.com 800-658-5958
SANI WASH
Spectrum™, a neutralpH concentrated liquid laundry detergent from Sani Wash, is formulated to be gentler on linens than high-alkali detergents often used in the hospitality and healthcare industries, says the company.
U.N.X. INC. U.N.X. offers the Deltatron, Tunneltron and Omegatron chemical injection systems.


The Deltatron can operate up to five washers with eight different chemicals. It dispenses exact amounts and combinations to precisely process any type of goods, the company says. The Omegatron delivers up to 10 chemicals to 10 washers, and both units will hold any washer with a problem to ensure properly cleaned linen.
Both the Omegatron and Deltatron offer low-level alarms, and allow for visually verifiable functions with full volumetric measurement of every injection so there is no opportunity to overuse chemicals, U.N.X. says.
The Tunneltron is a quick, reliable tunnel injection system that features proof of flow and delivery for every chemical and destination, the company says. It offers complete injection in less than 30 seconds with no tunnel hold. The Tunneltron offers simultaneous injections, simple alarm messages and quick summaries.
All three systems can be networked together for consolidated, real-time reporting, using Excel. www.unxinc.com 252-756-8616
KLIPPER GROUP
Longevity™ is a concentrated detergent from the Klipper Group that is designed for use in commercial, hospitality, and institutional laundries.
This surfactant technology system removes soil from a wide range of classifications without the need of chlorine bleach or hydrogen peroxide.
one of the more vexing stain issues in the healthcare laundry field: The Pink Monster—a skin sanitizer stain that won’t go away.
Gurtler’s new product, MagiClens™ chemical laundry product, also helps laundries eliminate changes to avoid the stains from Hibiclens®, Chlora-Prep® or similar chlorhexidene gluconate (CHG) products that healthcare partners often use, as well as addressing infection control issues faced by switching back to chlorine bleach.
www.gurtler.com 800-638-7300
METRO-CHEM
Metro-Chem recently introduced Solar-Solv, a biodegradable laundry additive used in conjunction with existing detergents to emulsify and remove all types of oily-based soils and stains on all laundry classifications.
Solar-Solv is a nonflammable mixture that is NPE-free and demonstrates low residual odor in finished work. It performs similarly to older laundry solvents that are no longer in use, the company says. A small amount of SolarSolv goes a long way to help with degreasing a wide range of soils and fabric types. It also works in all water temperatures, MetroChem adds.
The company says Solar-Solv works well on oil or grease stains on white and colored table linen, on mineral or petroleum-based stains on industrial uniforms, and on vegetable-based oils on shirts and foodservice uniforms.
www.metro-chem.com 800-332-7627
gram-positive bacteria (i.e. staph). This provides protection throughout the use cycle of the uniforms, linens and other textiles.
In addition, the sanitizer won’t irritate skin, the company says. The product is designed for use in healthcare facilities, nursing homes, institutional laundries, school and athletic team facili-
Spectrum™ has been reported to outperform other high-profile brand-name detergents and three-chemical systems in tests, Sani Wash reports. The product is designed to help operators lower linen-replacement costs, retain high cleaning standards, lower energy costs while seeing enhanced stain removal in lower temperatures, and eliminate the need for added pH-neutralizing chemicals.
Spectrum™ contains low-VOC (volatile organic compound) ingredients, which conforms to national safety guidelines. It is available in 5-, 15-, 30- and 55-gallon sizes. www.saniwash.com 718-729-1700




Proper use of the product helps provide better wash quality and fabric life, Klipper says. Wash formulas are typically shorter; use less water, energy and alkali; and use no solvents. www.klippergroup.com 877-KLIPPER
GURTLER INDUSTRIES
Gurtler Industries now offers a product designed to eliminate
SANTEC
Santec now offers Inspire, an eco-friendly green laundry detergent through the company’s Linden Series textile care program.
Inspire combines high performance with a formulation that helps preserve the fresh scent and soft feel to all fabrics, the company says. The detergent is designed for use in commercial laundries, hotels, motels, healthcare facilities, nursing homes, party rental companies and restaurants.
The concentrated low-foaming
16 DECEMBER 2013 | AMERICAN LAUNDRY NEWS www.AmericanLaundryNews.com [Anderson Chemical Co.] [Diamond Chemical Co.] [Gurtler Industries] [Santec]
[Sani Wash] [Edmar Chemical Co.]
[Metro-Chem]
[U.N.X.]
PRODUCT SHOWCASE
COMPILED BY JEAN TELLER, CONTRIBUTING EDITOR
[Team Systems]
detergent is composed of NPEfree surfactants and soy-based degreasing solvents to help clean stubborn oil-based stains. It penetrates and emulsifies these stains but doesn’t harm the environment while doing so, says the company. Inspire is also phosphate-free, and has been tested to perform well in both hard- or soft-water conditions.
www.cleanneeds.com 908-912-2500
ECOLAB
Ecolab recently introduced its Performance™ Industrial Program, which the company says will redefine industrial-strength cleaning. The NPE-free formulation delivers cleaning performance on all varieties of industrial soils for commercial laundries, the company says. With a sustainable product design, Ecolab offers chemistry for effective removal of petroleum, oil and grease while maintaining whiteness.
The new three-product system allows for customized formulas and helps create versatility to manage every application, Ecolab says.
www.ecolab.com 800-553-8683
maximizing load efficiency.

Rather than a single product, Compact One brings an overall total solution for compacting wash formulas without compromising wash quality, Christeyns says. Compact One will help a laundry reduce its ecological footprint while using green technology, free of NPE, phosphate, perborate, EDTA and NTA. www.christeyns.com 617-203-2169
SOFTROL
Softrol’s Catalyst Chemical Systems are designed for a broad
range of plant operations, from highvolume, heavy-soil processing to smallervolume operations. They use flow meterbased injection technology, providing volumetric injection and water flush verification.
Available in a wide variety of performance configurations for small- to large-volume facilities as well as tunnel washers, the Catalyst can fit the needs of a broad spectrum of chemical dispensing
needs, Softrol says.
Designed to handle a range of viscosities and injection volumes with accuracy and reliability, the Catalyst systems are available as redundant units to allow backup and additional load sharing between multiple units for those plants that need uninterrupted chemical delivery.
The Catalyst System interfaces with a PC for network communications.
Each comes with the PulseNet
Chemical Injection Module (PCIM) communications package, which allows access to data collected for each machine. The software also allows remote programming of injection formulas, system monitoring, and includes reporting for process load efficiency, process poundage, formula run times, formula chemical usage, and production efficiency.
Additional real-time display, utility monitoring and advanced web-based reporting software can be added.
www.softrol.com 888-763-8765 ALN

A.L. WILSON CHEMICAL CO.
When dealing with laundry stains, a laundry’s reputation rides on getting results. RiteGo laundry spray spotter, from A.L. Wilson Chemical Co., penetrates to absorb collar and cuff stains, perspiration, ground-in soil and more, all without brushing, according to the company. The product can be used on any fabric to be washed or wet cleaned.
The company also offers Laundry TarGo, for removing any oil-based stains that remain after processing with RiteGo.

Both products are chlorinated solvent-free, biodegradable, noncombustible and California 2013 VOC and Prop-65 compliant. www.alwilson.com 800-526-1188
CHRISTEYNS
Compact One is a total concept from Christeyns that brings a new way of washing to conventional washers. A combination of the right washing formulas with the right chemistry means a reduction of water usage by up to 50%, says the company, as well as a reduction of energy usage up to 30%.

Christeyns predicts increases in production with a reduced process time by up to 40% along with

www.AmericanLaundryNews.com AmericAn LAundry news | decem B er 2013 17
[A.L. Wilson Chemical Co.] american laundry news jr page 7.75x10 For laundry done on time and on budget, there’s no better choice than IPSO ®. Forty years of European ingenuity, rugged industrial construction, and our intuitive Cygnus controls all add up to help you achieve your ultimate goal — maximum throughput at a minimized cost. Learn more about how IPSO helps you get the job done at IPSO.com/industrial INDUSTRIAL BY DESIGN Work with your IPSO finance expert to learn about customized financial solutions for your business. IPSO USA 1.800.USA.IPSO IPSO.com/industrial INDUSTRIAL BY DESIGN. Optimal Efficiency. Maximized Throughput. 3929_IPSO OPL_jrPg amerlaundnews v2.indd 1 2/6/13 4:29 PM ALN_Jr Page.indd 1
[Softrol]
AmeriPride Services acquires SoCal Uniform’s San Gabriel, Calif., textile rental business
MINNEAPOLIS — AmeriPride Services recently acquired SoCal Uniform’s textile rental business in San Gabriel, Calif., and has begun servicing its new customer accounts out of its Los Angeles branch under the leadership of Annette Casemero, general manager, the company reports.
“SoCal Uniform has been serving the Southern California market since 1949, and this acquisition provides a great opportunity to expand our market share in the area while introducing new products and services to the customers,” says John Sutherland, AmeriPride senior vice president of operations. “We feel this is a great fit for our business and our new customers, and we are also excited to be adding some new employees from SoCal to our team.”
Both companies are “executing a seamless transition of the textile rental business to AmeriPride,” according to AmeriPride, which adds that some areas of SoCal’s business, including plant equipment and other assets, were not affected by the transaction.
“I am very confident in our ability to successfully service our new customers,” says Casemero. “Our L.A. production facility has the capacity and resources to take on the additional volume, and we are eager to incorporate the new customers and employees into our business.”
“InvoTech gives us an accurate, real-time inventory of all staff uniforms to protect our clothing investment efficiently and effectively,” says TreVina Johnson, employee labor relations manager for ThistleDown. “We had a major change in our operation and are now the sister property to Caesars Horseshoe Casino Cleveland, which also uses InvoTech. We use InvoTech to assign each uniform to specific team members and track the daily uniform requirement for all departments. This ensures we maintain continuous ‘room PAR,’ that is our wardrobe-room par stock, for all staff in every department.”
Johnson says the process to code the uniforms and enter them into the system for employee accountability was easy.
“Some of our staff launders their uniforms at home, and some departments, like our F & B teams, have uniforms dry cleaned. The InvoTech system tracks uniform movement, and provides reports that ensure we always have the right number of uniforms for all team members. It would be a labor-intensive job to track uniform inventories and processing by hand.”
Besides several other Caesars properties, other InvoTech clients include MGM Resorts International, Hyatt Hotels, Marriott, Hilton Hotels, Universal Studios Florida, Wynn Resort Las Vegas and Macau, Madison Square Garden, MSR-FSR Laundry, Empire State Building, Loews Hotels and Mandarin Oriental.
Lark to serve as IAHTM president for 2014; organization also names other new officers, board of directors
Sun Industrial Chemical industry knowledge and expertise into Miller’s current customer base, we believe a key component for providing our customers with exceptional janitorial supply expertise is now available from a single source.”
Alliance Laundry Holdings posts ‘record revenues’ for third quarter
RIPON, Wis. — Net revenues for Alliance Laundry Holdings LLC — the parent company of Alliance Laundry Systems — increased $16.1 million, or 12.7%, to $142.7 million from $126.6 million for the quarter ended Sept. 30, the company reports.
Net income decreased in the third quarter, however, down $2.6 million to $8.8 million, according to Alliance, while adjusted earnings before interest, taxes, depreciation and amortization (EBITDA) rose $0.3 million to $26.4 million.
The company attributes its net revenue increase for the third quarter to increases in U.S. and Canada revenues of $17.1 million and Europe revenues of $3.2 million, offset by lower Asia revenues of $1.6 million; lower Latin America revenues of $1.4 million; and lower Middle East and Africa revenues of $1.2 million.
Its net income decrease for the third quarter, according to the company, is attributable to higher interest expense of $4.5 million; higher selling; general and administrative expenses of $2.4 million and higher other costs of $0.3 million, offset by improved gross profit of $2.5 million and a lower provision for income taxes of $2.1 million.
MIAMI — World Emblem has recently added the position of territory account manager to its sales structure, the company reports.
“This new fleet of territory account managers (TAM) will be in charge of managing as well as building current customer relationships within their respective territories,” the company says. “By adding this new position, World Emblem will allow its sales force to work more closely with its existing customer base and develop new strategies on how to make its clients more profitable within their apparel decoration programs.”
The company’s customer base will be geographically divided into two sections, says World Emblem, with the western hemisphere of the United States under the guidance of Tony Morando, while Canada and the eastern hemisphere of the U.S. will be managed by Nicolas Restrepo.
Each regional VP will be in charge of a specific group of TAMS. A total of six TAMs will be added to World Emblem’s sales force; five within the United States and one in Canada, according to the company.
Each TAM will manage the portion of World Emblem’s customer base solely lying within a specific jurisdiction designated to that particular TAM.
“Consequently, due to the nature of the position itself, travel time will take up approximately half of their total work schedule, during which they will be making frequent visits to customers within their regions,” the company adds. “With varying backgrounds ranging from sales to plant management, our new fleet of TAMs is more than qualified to manage the responsibilities incumbent with their titles.”
SHAWNEE MISSION, Kan. — Following its Annual Member Meeting in Banff Springs, Alberta, the International Association for Healthcare Textile Management (IAHTM) has announced its officers and board of directors for 2014.
IAHTM officers for 2014 include President Deborah Lark, Portland Hospital Service Corp., Portland, Ore.; Vice President Rocco Romeo, Ottawa Regional Hospital Linen Service, Ottawa, Ontario; Treasurer Paul Seigel, Kingston Regional Hospital Laundry, Kingston, Ontario; Past President Ed McCauley, United Hospital Services, Indianapolis; and Past President John Sealey, London Hospital Linen Services, London, Ontario.
The board of directors includes three members from the United States and three from Canada.
U.S. directors are Education Director Myles Noel, COMTEX, Columbus, Ohio; Richard Bott, Intermountain Healthcare Central Laundry, Woods Cross, Utah; and Mark Smoyer, Shared Hospital Services, Portsmouth, Va.
Canada directors are Janice Desautels, WRHA, Winnipeg, Manitoba; Colin Lyon, Mohawk Shared Services, Hamilton, Ontario; and Malcolm Pallos, Cumberland Regional Hospital, Cumberland, B.C.
Nancy Jenkins is IAHTM’s executive director.
Miller’s Textile Service acquires Sun Industrial Chemical
WAPAKONETA, Ohio — Miller’s Textile Service, a regional supplier of linens, uniforms and janitorial supplies, reports that has acquired Sun Industrial Chemical, one of its long-time strategic alliance partners.
Sun, a janitorial supply company, has served Northwest Ohio for more than 30 years.
Net revenues for the nine months ended Sept. 30 increased to $35.0 million, or 9.4%, to $407.7 million, while net income increased $0.6 million to $23.5 million, the company further reports. Adjusted EBITDA for the same period increased $8.9 million to $77.8 million.
The net revenue increase of $35.0 million was attributable to increases in U.S. and Canada revenues of $31.9 million, and Europe revenues of $4.7 million, offset by lower Asia revenues of $0.6 million; lower Middle East and Africa revenues of $0.6 million; and lower Latin America revenues of $0.4 million, the company says.
“We are pleased to report record revenues for the third quarter, led by our largest geographic region, United States and Canada,” says CEO Michael D. Schoeb. “Revenue rose in almost every product category but was principally due to continued high demand for our small chassis products in the United States and Canada, as well as continued international growth in vended laundry. Notably, our organic sales growth of 12.7% marked the highest level achieved in the last five years.”
Mission Linen Supply expands service to 2nd Handlery Hotels property
SAN FRANCISCO — Mission Linen Supply has expanded its relationship with Handlery Hotels, the company reports. Having serviced Handlery’s San Diego property, Mission will now also supply the Handlery Union Square Hotel with bed linens, bath linens and bathrobes.
The Handlery Union Square Hotel is a three-and-a-half star hotel in the heart of San Francisco’s bustling Union Square neighborhood. It offers 377 rooms.
CLEVELAND — ThistleDown Racino is implementing InvoTech Systems’ uniform system to track uniforms for its 900 team members, InvoTech reports.
The racetrack recently reopened as a racino (racetrack/ casino), and is now operated by Caesars Entertainment.
According to Miller’s Textile Service, the deal provides an opportunity to increase its product offering and services to its customers.
“We always are working to provide clean, safe and attractive textile rental products to our customers,” says Miller’s President Robert Hager. “But now, by bringing 30 years of
“We are excited to have the opportunity to provide both hotels with a textile service program that meets their wide array of product and service requirements and provides consistency across both locations, which span the state of California,” says Mark Whitten, vice president of sales for Mission Linen Supply.
Mission will service the San Francisco and San Diego properties from two independent plants that provide local service to the metropolitan areas.
18 DEC E mBER 2013 | AmERiCAn LAunDRy nEws www.AmericanLaundryNews.com
World Emblem seeks to strengthen sales force by creating territory account manager positions
ThistleDown Racino racetrack/casino turns to RFID to track staff uniforms
ALN
MINNEAPOLIS — G&K Services’ Jeffrey L. Wright will retire as the company’s executive vice president and chief financial officer, continuing in his current role until June 2014 to ensure an orderly transition, the company reports.

The uniform rental and facility services company is searching for his successor, considering both internal and external candidates.
“I am grateful for the opportunity to have been a part of G&K Services, working together with such a talented team,” says Wright. “After thoughtful consideration, I have determined it is the right time to make this decision. The company is on sound footing, and has a bright future ahead. After working to support a smooth transition, I look forward to spending more time with my family and pursuing other professional and personal interests.”
Wright joined the company in 1999 and has served as CFO for nearly 15 years, according to G&K. He was promoted to executive vice president and was appointed to the company’s board of directors in 2009.
In addition to leading G&K’s finance division, he also led its
Track Career
GKdirect direct sale business, and oversaw the company’s cleanroom business and information technology department.

He’s contributed “significantly” to the company’s growth, says G&K, with “strong cash flow a consistent characteristic” during his tenure, and shareholders “enjoying a 15-fold increase in dividend payments.”
Outside the company, Wright served as chairman of the Textile Rental Services Association (TRSA) in 2008-2010.
“It has been my privilege to work alongside Jeff. He is a leader who truly personifies G&K’s core values,” says CEO Douglas A. Milroy. “Jeff’s leadership has been instrumental to G&K’s success. He has built a strong team and helped develop a companywide culture of financial and operational discipline, which will benefit G&K for years to come.”
Standard Textile’s Rau retires, Lee named successor
CINCINNATI — Standard Textile’s Carl Rau, laundry market manager, recently retired after seven years with the company, and Cecil Lee, who has more than 25 years of laundry industry experience, was named his successor, the company reports.

“We hired Carl to expand our
presence, enhance our reputation and grow our sales in the central/ co-op marketplace,” says John Wintz, group vice president. “This area of our business continues to grow, and being successful in the laundry industry remains a priority for Standard Textile.”
Rau brought 35 years of laundry experience to Standard Textile, working previously as a general manager and in business development for a national laundry outsourcing company.
“We appreciate all that Carl has done over the years and wish him a successful retirement,” says Wintz. “We look forward to welcoming Cecil and appreciate the expertise he will provide to all of our valued customers in the laundry marketplace.”
A graduate of the University of Michigan and Central Michigan University, Lee has vast industry experience, having worked for a national laundry company and other laundries in Ohio, Michigan and New York, the company says.


“I am very excited about coming to work for Standard Textile,” says Lee. “The company is a premier manufacturer and supplier to the healthcare workplace. I look forward to continuing Carl’s
great work and servicing our customer needs in the central/co-op marketplace.”
Ellis Corp. welcomes two new hires

ITASCA, Ill. — Ellis Corp. has hired Chris Giordano as field service manager, and Don Kirkland as field service technician, the company reports. Prior to joining the company, Giordano recently served as chief engineer at Angelica, Chicago, for six years, and at Alsco, Chicago, for eight years, according to Ellis Corp.
“We are excited to have Chris on board, and know that his experience will be a great asset to us,” says Bob Fesmire Jr., executive vice president and chief operating officer of Ellis Corp. “We look forward to drawing on his experience as a former chief engineer to better serve our customer needs.”
Kirkland also brings many years of industry experience to the company, having working previously for Milnor for 10 years, and, most recently, for Kannegiesser for 12 years, Ellis


Corp. adds.
“Don’s expertise is with the installation, project management and servicing of automated wash systems,” says Fesmire. “We are very excited to have him on board and know that his vast experience will be a great asset to us.”
Schlimgen joins Girbau Industrial
OSHKOSH, Wis. — Hollywood, Fla., native Matthew Schlimgen recently joined Girbau Industrial (GI) as its North American technical manager, the company reports.
In his new role, Schlimgen provides technical leadership for GI, Continental Girbau Inc. and Girbau S.A.; manages GI’s North American technical service program; handles on-site coordination of GI industrial laundry product and system installations; provides post-sale technical support; and closely interfaces with the company’s product development and improvement teams.
A veteran field service manager, Schlimgen brings to Girbau 14 years of industry experience, having managed plant automation, performance, maintenance and repair.
Prior to joining GI, he served as chief plant engineer at Alsco and Crown Linen in Miami. ALN



Wright to retire as G&K executive VP, CFO in June
www.AmericanLaundryNews.com AMERICAN LAUNDRY NEWS | DECEMBER 2013 19
Giordano
Kirkland
Schlimgen
Wright
Lee Rau







20 DECEMBER 2013 | AMERICAN LAUNDRY NEWS www.AmericanLaundryNews.com www.cornerstonemachinery.com Quality used and reconditioned equipment Rigging and relocation services Satisfaction guaranteed Complete inventory on our website Please call or email John or Eric john@cornerstonemachinery.com eric@cornerstonemachinery.com 877-773-1850 PARTS, PARTS, PARTS Huge stock of parts for most laundry equipment & boilers. Also traps, valves and lubricants. Overnight delivery. Steiner-Atlantic, 800-333-8883 Fax: 305-751-8390 parts@steineratlantic.com www.steineratlantic.com WASHEX PARTS Hard-to-find Washex parts, on-site rebuilding, tech support. LAUNDRY PARTS CENTER 800-352-4492 Fax: 305-827-3991 Classified Advertising PARTS FOR SALE EQUIPMENT FOR SALE EQUIPMENT FOR SALE AMKO AMERICA, INC. Remanufactured Finishing Equipment Delta Ironers, Omega Folders & Towel Folders (1 year parts warranty) Like new at half the cost. PARTS, IRONER SUPPLIES & NEW EQUIPMENT ALSO AVAILABLE Contact: (561) 863-9696 jurgenb@bellsouth.net POSITIONS AVAILABLE www.ineedjpequipment.com 800/925-3236 EQUIPMENT FOR SALE: (2) 800lb American L-Trons HOT – Ready to go – Make offer! (1) 2003 Lavatec Tunnel Press, LP582 - 150lb (1) Rebuilt Milnor CBW Module, 110lb, new hardware (1) Kaeser air tower 26, 25 hp with dryer (1) Easy roll mat roller (1) 250lb Braun OP (Rebuilt/Ready to Ship) (1) 2010 Chicago 136” wide King Edge w/Vac (1) 1996 Chicago Blanket Folder (2) 400lb Brim OP Washer/Extractor (1) 6-Mod 135 G3 Milnor Tunnel (Can make complete system) (1) 2000 4-Lane Chicago Skyline Folder/No Side Discharge (1) 1999 4-Lane Chicago Skyline Folder (w/Optional Built-In Single Lane) (1) 1999 Single-Lane Chicago Skyline Folder (1) 1997 Single-Lane Chicago Skyline Folder (4) 2001 110lb Milnor Tunnel System Dryers (1) 2004 Chicago Thermal 32” 2-Roll Ironer Light Tables for Pack Room “Expect Excellence” MISSED OUR DEADLINE? DISTRIBUTOR OFFERINGS DISTRIBUTOR OFFERINGS AmericanLaundryNews.com More than unique visitors monthly! Expect excellence from the leader in used industrial laundry equipment sales and installation. Keep up to date with equipment for sale, and the latest industry news by subscribing to our monthly newsletter. Go to www.ineedjpequipment and sign up TODAY! About JP Equipment JP Equipment is a trusted, full-service, used industrial laundry equipment sales and installation company. We pride ourselves on providing unparalleled Call Craig Lloyd toll free at (877) CWL-LOYD between 9 a.m. – 9 p.m. EST. Please visit www.laundrycareers.com to review current industrial/institutional laundry management openings. ADVANCE YOUR CAREER PLACE YOUR AD ONLINE: www.AmericanLaundryNews.com The Griffin Group, Inc. “Recruitment Specialist” Need to FILL a position? Call Deana Griffin 888-235-2365 www.thegriffingroup.cc deana@thegriffingroup.cc ® Stanco Industries, Inc. Serving The Textile Trades Since 1970 stanco2626@aol.com 800-932-3769 Visit Our Website: www.stancoind.com -------------- Equipment For Sale -------------1999 Milnor 12-Mod CBW. Complete 2012 Chicago 2-Roll 32 Thermal 2003 Chicago Skyline S20 2002 Chicago King Edge 2000 Jensen 12-Module CBW 2007 ADC 170# Gas 2005 Challenge 400# Gas Pacesetter 2-door 1997 Milnor 135# w/e EP-Plus. 2 available. 2006 Fulton 100hp., 150psi Boiler System 2006 Ludell 5M Btu Direct Contact ------- BOILERS • WATER HEATERS • CARTS “Many items can be viewed in operation” “We buy single items and complete plants” Stanco recycles everything KEEPING IT GREEN SINCE 1970 5,250 Place your ad ONLINE! QTY DESCRIPTION 1 Unipress Vacuum Single Buck Shirt Unit 2 Milnor 120lb Steam Dryers 2006 1 Shaper Steam 12” Ironer by 120 1 Chicago Comet Ironer 2008 1 Wascomat Soft Mount 30lb Washer 1 Wascomat Soft Mount 50lb Washer 2 Milnor 36026V5J 100lb Washers 2004 2 Milnor M122 Gas Dryers 1 Cissell 55 1PH High Speed Washer 1 Chicago Pik-Quik For Pricing call Ron Hirsch 516.938.4300 • 516.315.7426 Hicksville, NY www.directmachinery.com FOR NEW OR USED LAUNDRY EQUIPMENT, DM IS YOUR SOURCE FOR ALL YOUR NEEDS We Buy Used Equipment • Pictures on website
Sani Wash - McClure Industries, Inc. 9051 SE 55th Ave., Portland, OR 97206 800-752-2821 www.mcclureindustries.com, info@mcclureindustries.com

























www.AmericanLaundryNews.com AmericAn LAundry news | decem ber 2013 21 source directory A convenient guide to sources of products and services APPAreL FinisHinG cArTs, TrucKs & bAsKeTs Energenics Corp., Kartwasher 1470 Don St., Naples, FL 34104 800-944-1711 www.energenics.com cHemicALs/inJecTOr sysTems Gurtler Industries, Inc. 15475 S. LaSalle St., South Holland, IL 60473 800-638-7300, Fax: 708-331-1210 www.gurtler.com Pellerin Milnor Corp. P.O. Box 400, Kenner, LA 70063 504-467-9591, Fax: 504-468-3094 www.milnor.com dryers – 100 POunds Or mOre Choose your favorite low-cut front for ergonomic access, roll safe and easy on advanced poly base with premium casters—all included as standard. Easy Reach, Easy Roll Call 800.829.4535 or visit MODLaundry.com for a FREE QUOTE. 72P 72N Meese Orbitron Dunne Co. BULK DELIVERY TRUCK Rugged, non-marring trucks designed to maximize payload Up to 63.5 cu. ft. capacities in 13 different sizes. l-800-275-2436 RepsAvailable8 AM-8 PM (EST) maxi-movers.com Fax: 631-661-8209 •Email:sales@maxi-movers.com The Cart Guys Chm #9534 Bulk Del. ALN Class. 11/5/13 11:33 AM Source Directory listings in American Laundry News are sold on an annual basis at the following rates: All Major Credit Cards Accepted 2014 Listings Regular Boldface All Caps All Caps, Boldface Four Line Listing per Year $820 $1,030 $1,030 $1,090 Display and additional line rates available upon request cArT-wAsHinG sysTems Sani Trux - McClure Industries, Inc. 9051 SE 55th Ave., Portland, OR 97206 800-752-2821 www.mcclureindustries.com, info@mcclureindustries.com M.I.T. POLY-CART 211 CENTRAL PARK WEST, NEW YORK, NY 10024 800-234-7659, FAX: 212-721-9022 WWW.MITPOLYCART.COM cArTs, TrucKs & bAsKeTs cArTs, TrucKs & bAsKeTs Pellerin Milnor Corp. P.O. Box 400, Kenner, LA 70063 504-467-9591, Fax: 504-468-3094 www.milnor.com dryers – 100 POunds Or Less Rotational Molding, Repair, Recycling...Your Complete Plastic Solution 11744 Blue Bell Rd. Elberfeld IN 47613 800-304-4600 www.fibertechinc.net EMPLOYEE LOCKERS EMPLOYEE LOCKERS For Your Linen Stockers For Your Linen Stockers Diversified Plastics, Inc. 1309 Highway 917 West, Latta, SC 29565 800-768-7636, www.dpirotocarts.com E-mail: sales@dpirotocarts.com, Fax: 843-752-7798














22 DECEMb E r 2013 | AMEriCAn LAunDry nEws www.AmericanLaundryNews.com Source Directory listings in American Laundry News are sold on an annual basis at the following rates: All Major Credit Cards Accepted 2014 Listings Regular Boldface All Caps All Caps, Boldface Four Line Listing per Year $820 $1,030 $1,030 $1,090 Display and additional line rates available upon request Gardner Machinery Corporation P. O. Box 33818, Charlotte, NC 28233 Ph.: (704)372-3890; Fax: (704)342-0758 www.gardnermachinery.com MAtEriAL HAnDLing / ConvEyors source Directory A convenient guide to sources of products and services FLAtworK ironErs Setting the Standard in Lint Filters for 25 Years • Hotel • OPL • Coin Op • Dry Cleaners • Industrial • Commercial • Cruise Industry Dry or Wet Style Filters to Work with “ALL” Dryer Sizes or Multiple Situations, Fiberglass or Stainless and Custom for Unique Situations! All manufacturing done on premise 800-826-1245 www.cleancyclesystems.com • ccsystems@tqind.com pArts contact us to book your ad today! classifieds@americantrademagazines.com Knowhow In Action Your Tingue rep is a fully trained master of finishing equipment operation, maintenance and installation. Call for: • Pads, covers, belts, waxes, tapes and more • Carts, trucks, baskets and bags • Parts, rebuilds and repairs 800.829.3864 www.Tingue.com TalleyMachinery.com MODLaundry.com TBR-Associates.com To website FLAtworK support www.olekbelts.com 1-800-869-2683 Free www.olekbelts.com We’re your flatwork finishing and conveying O.E.M. Belt Match H.Q. Get the real thing for a Lot less $$$. O.E.M. Needlefelt Ironer Pads too! Better Belts, Better Prices, Better Service Visit our Website or Call 1-800-869-2683 For free, no obligation, price quotations and for your Free copy of our Product Catalog with over 40 samples. Ironer pads, covers, aprons, guide tapes, carts, slings, cleaners, waxes & more… Lint CoLLECtors & FiLtErs H Our In-Line Lint Filter mounts inside, saves space! H Fiberglass Wet Filters - 6,000 to 40,000 cfm H Fiberglass or Stainless Steel Dry Filters ENERGENICS CORPORATION Talk with our Design and Engineering Staff about your needs. Hundreds Sold Annually. 800-944-1711 www.energenics.com pArts C & W EQUIPMENT (800) 443-3573 FLATWORK IRONER SPECIALISTS REMANUFACTURED IRONERS: Super Sylon Sylon Hypro’s Super Pro Jensen SS700 SS800 Ultima Lavatec UPGRADE KITS: Chain Drive Conversion Vacuum Systems Herringbone Conversion Canopies Inverters Side Covers Roll Springs Jensen Drives SUPPLIES: Aprons Pads Covers Belts Waxes Cleaners PARTS/REPAIRS: All Brands New/Refurbished/Hard to Find COMMITTED TO EXCELLENCE Get the info you need online... AmericanLaundryNews.com 2013aln_aln.com_class.indd 1
Pellerin Milnor Corp. P.O. Box 400, Kenner, LA 70063 504-467-9591, Fax: 504-468-3094 www.milnor.com
TYING MACHINES
FELINS USA, Inc. Milwaukee, WI Tying, Banding & Automated Shrink Wrap Systems 800-843-5667 sales@felins.com For more information visit us at www.felins.com


WASHERS – CONTINUOUS BATCH












Pellerin Milnor Corp.
P.O. Box 400, Kenner, LA 70063 504-467-9591, Fax: 504-468-3094 www.milnor.com
WASHER-EXTRACTOR
Pellerin Milnor Corp.
P.O. Box 400, Kenner, LA 70063 504-467-9591, Fax: 504-468-3094 www.milnor.com
WASHER-EXTRACTOR

Pellerin Milnor Corp.

















P.O. Box 400, Kenner, LA 70063 504-467-9591, Fax: 504-468-3094 www.milnor.com

www.AmericanLaundryNews.com AMERICAN LAUNDRY NEWS | DECEMBER 2013 23
– 100
POUNDS OR LESS
– 100
MORE
POUNDS OR
PRESSES – EXTRACTION Source Directory A convenient guide to sources of products and services PLANT DESIGN & INSTALLATION Source Directory listings in American Laundry News are sold on an annual basis at the following rates: All Major Credit Cards Accepted 2014 Listings Regular Boldface All Caps All Caps, Boldface Four Line Listing per Year $820 $1,030 $1,030 $1,090 Display and additional line rates available upon request Company Web Site Page Company Web Site Page INDEX OF ADVERTISERS American Dawn www.americandawn.com 7 Cornerstone Equipment & Rigging www.cornerstonemachinery.com 20 Davis Packaging www.davispackaging.net 19 Direct Machinery Sales Corp. www.directmachinery.com 20 The Griffin Group, Inc. www.thegriffingroup.cc 20 G.A. Braun www.gabraun.com 11 Gurtler www.gurtler.com 3 IPSO www.ipso.com 17 J.P. Equipment www.ineedjpequipment.com 20 LaundryCareers.com www.laundrycareers.com 20 Lavatec Laundry Technology www.lavatec-laundry.com 24 LG www.lgcommerciallaundry.com 5 NATCO www.nationalcombustion.com 19 Royal Basket Trucks www.royal-basket.com 15 Stanco Industries www.stancoind.com 20 THE WIRE The latest news, straight to your inbox, 2X a week A & B WIPER SUPPLY You’re probably not getting enough for your linen discards! We pay TOP DOLLAR for your discarded sheets, towels, thermal & flannel blankets. Call us for an immediate quote: 800-333-RAGS (7247) We’re Hiring! Textile Buying & Sales Executive Positions Available E-mail Résumés to resumes@bestrags.com RAGS WANTED FOR CASH OR TRADE











































































 By Josh stEinhARDt
By Josh stEinhARDt